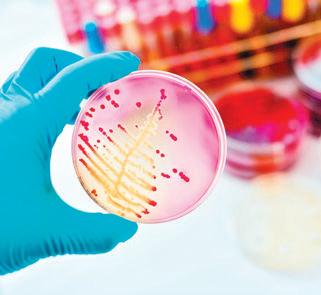
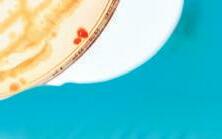
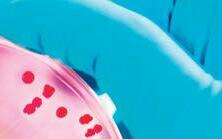
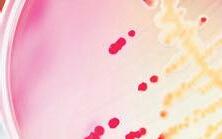
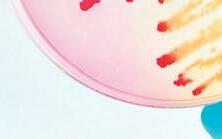
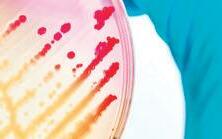
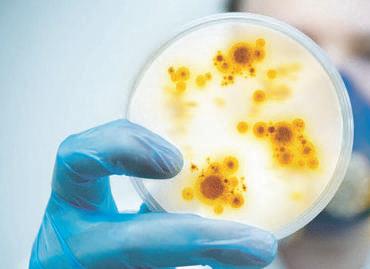

Recently the Ford government sent a letter to family clinics, urging them to stay open evenings and weekends. Another desperate measure to take the pressure off hospitals that are buckling under the load of too many patients. It’s a typical move for this government - asking others to cover for their own mistakes.
The thing is, many family clinics are already maxed out. Ontario’s healthcare workers have been on high alert for three years now. They don’t have much left to give. Nurses in particular are overworked and burned out. And they’re sick of a government that refuses to acknowledge a truth that everyone inside the system can see: the health-care crisis is a direct result of the way this government deliberately undervalues the workers whose dedication keeps the system alive.
Every day, the consequences of Ford’s political arrogance become clearer. When pressed, he shrugs his shoulders and says, “We’re doing the best we can.” That just won’t cut it. Doug Ford, this is on you.

Across Canada, people are going without the health care they need. Emergency rooms waits are counted in days not hours. Far too many Canadians, even those with critical illnesses, have no primary care provider or the wait for an appointment is too long and so they must turn to walk-in clinics or wait in crowded emergency rooms.
Hospital staff and their families are falling sick from COVID-19 and unable to work or, burnt-out, retire early or change jobs. This is unsurprising, after nearly three years of battling wave after wave of COVID-19, and with the coming winter months threatening a further surge.
Provincial governments, instead of responding to the problem with the urgency required, have launched a media campaign for more federal funding. The federal government has been content to sit on its hands, avoiding responsibility for health care, spinning the same old yarn that responsibility rests with the provinces. Medical associations stick to the refrain of needing more investments largely in support of the status quo and/or calling for reforms that will have little or no immediate impact for patients.
It is a dangerous time for public medicare and for Canadians. Pro-privatization doctors and associated businesses are pushing hard to take advantage of Canadians’ fears and frustration that their loved ones will suffer with unmet health needs.
But the promises of reduced wait times through privatization ring false for most Canadians.
The pandemic has seriously impacted the supply of nurses and doctors. If the rich or well insured can pay more for care, then the current access problems will worsen for all those who have no choice but to rely on public medicare.
Privatization would also mean Canadians in remote and rural areas would face even greater hurdles to access care as physicians migrate to metropolitan areas to provide more lucrative services to urban dwellers. Higher prices paid to doctors and nurses in the private tier would also increase the prices that would have to be paid by public medicare to keep them in the system.
If privatization is a snake-oil solution, what is to be done? We need to apply pressure to both levels of government to attend to this crisis now.
Provinces need to take bold steps, including:
• Alleviate the administrative burden and cost of business on doctors by setting up publicly run clinics staffed by family practice teams paid on a salary basis.
• Immediate increase in nurses’ pay and higher fee per patient for those family doctors who add high-need patients to their rosters.
• Permit additional billing for virtual care for primary care teams willing to enrol more patients and to enable both family doctors and specialists to provide additional services to patients in remote and rural areas.
• Establish urgent care centres to divert more non-critical patients from the emergency department.
610 Applewood Crescent, Suite 401 Vaughan Ontario L4K 0E3
TEL. 905.532.2600|FAX 1.888.546.6189 www.hospitalnews.com
Barb Mildon, RN, PHD, CHE
VP Professional Practice & Research & CNE, Ontario Shores Centre for Mental Health Sciences

Helen Reilly, Publicist Health-Care Communications
Jane Adams, President Brainstorm Communications & Creations
Bobbi Greenberg, Health care communications Sarah Quadri Magnotta, Health care communications
Dr. Cory Ross, B.A., MS.C., DC, CSM (OXON), MBA, CHE
Vice President, Academic George Brown College, Toronto, ON
SUPPLEMENT
THANKS TO OUR ADVERTISERS Hospital News is provided at no cost in hospitals. When you visit our advertisers, please mention you saw their ads in Hospital News.
Hospital News is published for hospital health-care professionals, patients, visitors and students. It is available free of charge from distribution racks in hospitals in Ontario. Bulk subscriptions are available for hospitals outside Ontario.
The statements, opinions and viewpoints made or expressed by the writers do not necessarily represent the opinions and views of Hospital News, or the publishers.
Hospital News and Members of the Advisory Board assume no responsibility or liability for claims, statements, opinions or views, written or reported by its contributing writers, including product or service information that is advertised.
Changes of address, notices, subscriptions orders and undeliverable address notifications. Subscription rate in Canada for single copies is $29.40 per year. Send enquiries to: subscriptions@ hospitalnews.com
Canadian Publications mail sales product agreement number 42578518.
Researchers from The Hospital for Sick Children (SickKids) have uncovered new genes and genetic changes associated with autism spectrum disorder (ASD) in the largest autism whole genome sequencing analysis to date, providing better understanding into the ‘genomic architecture’ that underlies this disorder.
The study, published today in Cell, used whole genome sequencing (WGS) to examine the entire genomes of over 7,000 individuals with autism as well as an additional 13,000 siblings and family members. The team found 134 genes linked with ASD and discovered a range of genetic changes, most notably gene copy number variations (CNVs), likely to be associated with autism, including ASD-associated rare variants in about 14 per cent of participants with autism.
The majority of data was drawn from the Autism Speaks MSSNG database, the world’s largest autism whole genome dataset, which provides autism researchers with free, open access to thousands of sequenced genomes.
“By sequencing the entire genome of all participants, and with deep involvement from the participating families in MSSNG on forming our research priorities, we maximize the potential for discovery and allow analysis that encompasses all types of variants, from the smallest DNA changes to those that affect entire chromosomes,” says Dr. Stephen Scherer, Senior Scientist, Genetics & Genome Biology and Chief of Research at SickKids, and Director of the McLaughlin Centre at the University of Toronto.
Dr. Brett Trost, lead author of the paper and a Research Associate in the Genetics & Genome Biology program at SickKids, notes the use of WGS allowed researchers to uncover variant types that would not have otherwise been detectable. These variant types include complex rearrangements of DNA, as well as tandem repeat expansions, a finding supported by recent SickKids research on the link between autism and DNA segments that are repeated many times. The role of the
maternally inherited mitochondrial DNA was also examined in the study and found to account for two per cent of autism.
The paper also points to important nuances in autism genetics in families with only one individual with autism compared with families that have multiple individuals with autism, known as multiplex families. Surprising to the team was that the “polygenic score” – an estimation of the likelihood of an individual having autism, calculated by aggregating the effects of thousands of common variants throughout the genome – was not higher among multiplex families.
“This suggests that autism in multiplex families may be more likely to be linked to rare, highly impactful variants inherited from a parent. Because both the genetics and clinical traits associated with autism are so complex and varied, large data sets like the ones we used are critical to providing researchers with a clearer understanding of the genetic architecture of autism,” says Trost.
The research team says the study data can help expand inquiries into the range of variants that might be linked to ASD, as well as efforts to better understand contributors to the 85 per cent of autistic individuals for which the genetic cause remains unresolved. In a linked study of 325 families with ASD from Newfoundland published this same month in Nature Communications, Dr. Scherer’s team found that combinations of spontaneous, rare-inherited, and polygenic genetic factors coming together in the same individual can potentially lead to different sub-types of autism.
Dr. Suzanne Lewis, a geneticist and investigator at the BC Children’s Hospital Research Institute who diagnosed many of the families enrolled in the study said, “Collectively, these latest findings represent a massive step forward in better understanding the complex genetic and biological circuitry linked with ASD. This rich data set also offers an opportunity to dive deeper into examining other factors that may determine an individual’s chance of developing this complex condition
to help individualize future treatment approaches.”
Funding for this study was provided by the University of Toronto McLaughlin Centre, Genome Canada/ Ontario Genomics, Genome BC, Government of Ontario, Canadian
Institutes of Health Research, Canada Foundation for Innovation, Autism Speaks, Autism Speaks Canada, Brain Child, Kids Brain Health Network, Qatar National Research Fund, Ontario Brain Institute, SFARI and SickKids Foundation. ■ H

new one-stop guideline takes a 360-degree approach to managing heart disease in Canadian patients, with 83 recommendations in one easy-to-use reference. The guideline is published in CMAJ (Canadian Medical Association Journal).
“Clinicians are rightly concerned that there are too many guidelines with too many individual recommendations to be practical and useful for daily use, particularly in primary care. Typical patients with multiple illnesses require the access to many guidelines at the same time, and some recommendations are not harmonized and often seem contradictory,” says Dr. Peter Liu, chief scientific officer at the University of Ottawa Heart Institute, and a senior author of the latest C-CHANGE guideline. “We hope this fourth update to the very popular C-CHANGE guideline will further meet the needs of health professionals and patients, to prevent and treat cardiovascular conditions and associated
brain health with a simple harmonized approach.”
An update to a 2018 publication, the Canadian Cardiovascular Harmonized National Guideline Endeavour (C-CHANGE) resource includes 48 new or revised recommendations out of the 83, from 11 cardiovascular-focused guideline groups across the country.
Aimed at primary care and other health care providers, the C-CHANGE guideline contains actionable recommendations for Canadian adults with or at risk of cardiovascular disease, including • people with obesity, diabetes or hypertension; • people with dyslipidemia, atherosclerotic vascular disease or heart failure; and • people with atrial fibrillation, stroke or dementia.
It also includes health behaviour recommendations for all Canadians to address risk factors for these conditions, such as dietary, smoking and physical activity considerations.
• Establish a central triage system for specialists so that those in high need in a region or province are directed to the first available diagnostic spot or specialist.
Canadians should also demand the federal government take every step it can to improve public medicare immediately.
Emergency federal funding is needed but must come with a fair request that provinces be transparent with their budgets and outline the difference any new investments from the federal government will make.
Why? Premier Ford in Ontario has sat on billions of dollars of federal funding for the COVID-19 response, for example. The citizens of Ontario deserve to know how every single new federal dollar will be invested to improve public medicare now.
The federal government should also flex all its other levers of constitutional powers to support public medicare at this time. This includes further investments to support fast-track accreditation of the thousands of immigrant health care workers across Canada who want to work but are not permitted to do so.
The federal government should also create a Medicare Ombudsman to hear and document the concerns of patients so we can have a clear sense of both distinct and common issues across the country.
There is a window of opportunity in this moment of crisis to radically improve public medicare. But this crisis also presents an unprecedented opening for those who seeking to profit from the erosion of public services and our collective faith in the public system.
Canadians need to stand up for public medicare now, for they will sorely miss it when it’s gone. ■ H
Colleen M. Flood is the University of Ottawa Research Chair in Health Law & Policy and Director of the University of Ottawa Centre for Health Law, Policy and Ethics.
“C-CHANGE is all about singing from the same song sheet,” says Dr. Sheldon Tobe, co-chair of C-CHANGE and nephrologist at Sunnybrook Health Sciences Centre. “Our goal is to help health care providers understand the evidence for best practices, and if they can follow the guidelines, the health of the Canadian population could substantially improve.”
What’s different from before?
More than 50 per cent of the guideline contains new or revised recommendations from the previous 2018 version. This guideline is also more comprehensive and holistic in caring for patients with multimorbidity.
Partnership has expanded to include Health Canada’s Dietary Guideline, the Canadian Consensus Conference on Diagnosis and Treatment of Dementia, and the Canadian Cardiovascular Society/ Canadian Heart Rhythm Society guide-
line for the management of atrial fibrillation. It also includes a subsection on depression given its frequent co-existence and impact on cardiovascular disease.
“In the past four years, many of the national guideline organizations have launched new, evidence-based recommendations – from changes in medication management to new thresholds for lipid levels in secondary prevention,” says Dr. Rahul Jain, co-chair of C-CHANGE and family physician at Sunnybrook Health Sciences Centre. “We hope this resource helps primary care clinicians stay up to date with many constantly evolving cardiovascular guidelines, so their patients can get the best care possible.”
“Canadian Cardiovascular Harmonized National Guideline Endeavour (C-CHANGE) guideline for the prevention and management of cardiovascular disease in primary care: 2022 update” was published November 7, 2022. ■ H
With rising mental health care needs and Emergency Departments stretched past their limits, Canada must act now to cover mental health care, both before and after people are in crisis. So says the Canadian Mental Health Association (CMHA) with a network of Canadian organizations as they launch Act for Mental Health, an advocacy campaign calling for the creation of the promised Canada Mental Health Transfer.
Mental illnesses and substance use disorders will affect one in three Canadians in their lifetime, and research shows the pandemic made things worse. Of those millions of people, one in three can’t get the care they need. Some will wind up in Emergency Departments.
“When someone is in a mental health crisis, all roads lead to a hospital,” says Margaret Eaton, CMHA National CEO. “There is often nowhere else to turn, but Emergency Departments aren’t the cure for our mental health crisis.” Eaton goes on to say: “We’re also failing people once a crisis
passes. Often, they’re discharged without the care they need because it either does not exist, or it isn’t covered.”
Under the Canada Health Act, mental health care is only covered by public health insurance when it is provided by physicians and/or in hospitals, Millions of Canadians don’t have a family doctor and can wait months, or more, to see a psychiatrist. Family doctors face challenges in caring for patients with mental health concerns, and publicly funded referral options are scarce.
As a conservative estimate, Canadians pay over $1 billion every year on private psychological services alone. While some free mental health and substance use health services exist, persistent underfunding to community-based agencies means wait lists are long and services are limited. When we can’t afford to pay, often we don’t get the care we need, which can lead to crisis and to hospital.
Canadians are encouraged to Act for Mental Health by visiting www. actformentalhealth.ca and getting involved. ■ H
The Ontario Pharmacists Association (OPA) has partnered with MAPflow, a powerful new digital health tool to support pharmacists when they assess and prescribe for minor ailments in the province starting January 1, 2023.
Minor ailments are health conditions that can be managed with minimal treatment and/or self-care strategies. They are often short-term conditions where lab results aren’t typically necessary, and there’s a low risk of treatment masking underlying conditions.
Pharmacists manage highly confidential patient data and must meet
strict privacy, security, and governance requirements when implementing minor ailments services next year. As they transition to the expanded role, MAPflow’s advanced software platform streamlines documentation, offering pharmacists a simplified workflow and seamless experience.
OPA’s investment in this web-based clinical decision-making and implementation support platform provides pharmacists with a comprehensive suite of custom-built applications designed for Ontario’s practice environment.
“As the unified voice representing thousands of Ontario pharmacy
professionals, OPA works with government in enabling pharmacists to create additional capacity in healthcare,” notes Jennifer Belcher, RPh., a practicing pharmacist and VP of Strategic Initiatives and Member Relations at OPA. “We’re committed to helping pharmacists increase agility and drive innovation for the future. OPA has invested in MAPflow to successfully prepare pharmacists to make confident, evidence-based decisions while assessing patients for minor ailments.”
MAPflow is industry-specific software designed by a team of leaders in Ontario pharmacy education, led by community pharmacist and academic Nardine Nakhla, PharmD.
Alarge study found that myocarditis after SARSCoV-2 vaccination was rare but higher in younger males, especially after the second mRNA-1273 (Moderna) vaccine, suggesting that vaccine type, age and sex should be considered when vaccinating. The study is published in CMAJ (Canadian Medical Association Journal).
“In this study, we found higher observed rates of myocarditis after receipt of mRNA vaccines than expected, but absolute rates were low,” writes Dr. Naveed Janjua, School of Population and Public Health, University of British Columbia and the British Columbia Centre for Disease Control, Vancouver, BC, with coauthors.
Researchers analyzed population health data from the BC COVID-19 Cohort, which included more than 10.2 million doses of mRNA vaccines administered to people aged 12 years and older from Dec. 15, 2020, to Mar. 10, 2022. Almost seven million were BNT162b2 (Pfizer-BioNTech) doses and 3.2 million were mRNA-1273 (Moderna) doses. The researchers identified people who were admitted to hospital or visited an emergency department because of myocarditis
within seven and 21 days of receiving the vaccine.
On average, the rate of myocarditis 21 days after vaccination was 1.37 per 100 000 people compared with an expected rate of 0.39 per 100 000 people not vaccinated. The highest rates of myocarditis were in males (rate: 2.15/100 000), among those aged 18–29 (rate: 2.97/100 00), after the second dose (rate: 2.27/100 000 doses) and in people vaccinated with mRNA-1273 (Moderna) (rate: 1.75/100 000). Among males aged 18–29 who received the mRNA1273 (Moderna) vaccine, the rate was 22.9/100 000 doses. After the third dose, rates of myocarditis were lower, including among people aged 18-29.
“The overall rates of myocarditis per 100 000 doses were still very low for both vaccine products,” write the authors. However, they state that their findings “… support the preferential use of the BNT162b2 (Pfizer-BioN-
Tech) vaccine over the mRNA-1273 (Moderna) vaccine for people aged 1829 years.”
A US analysis estimated that 11 000 COVID-19 cases, 560 hospital admissions, 138 ICU admissions and 6 deaths from COVID-19 could be prevented per million second doses of mRNA SARS-CoV-2 vaccine administered to males aged 12–29 years, compared with 39–47 expected cases of myocarditis after SARS-CoV-2 vaccination.
“[T]he benefits of vaccination against SARS-CoV-2 in reducing the severity of COVID-19, hospital admission and deaths far outweigh the risk of developing myocarditis.… Thus, continued vaccination of this group, along with monitoring of adverse events, including myocarditis, should remain the preferred strategy,” the authors conclude.
“Observed versus expected rates of myocarditis after SARS-CoV-2 vaccination: a population-based cohort study” was published Nov. 21, 2022. ■ H
Through Dr. Nakhla’s research and significant expertise in minor ailments, she recognizes the importance of reliable, resilient, interconnected health systems. The pandemic further highlighted the need for multifaceted, sustainable primary and community-based healthcare solutions. “MAPflow facilitates minor ailment prescribing services for pharmacists and integrates this new element into their practice while optimizing patient outcomes,” notes Dr. Nakhla. “This exciting tool captures unique analytics, promotes shared clinical decision-making, and aligns with provincial legislation. Most importantly, it enables pharmacists to provide patients with customized care.” The approach aligns with the Ministry of Health’s objective to provide more pathways for patients to access care in the community and reduce the need for emergency or urgent care visits.
Partnering to launch this tool demonstrates OPA’s visionary leadership and proud role as a driving force for modernization and digital health transformation. These strategic investments represent a key feature of the Association’s long-term vision toward expanding the scope of practice for pharmacy professionals.
To learn more about MAPflow and purchase a subscription for this specialized program, visit opatoday.com. ■ H
Study finds that risk of myocarditis after SARSCoV-2 vaccination is increased but very low
THE PANDEMIC FURTHER HIGHLIGHTED THE NEED FOR MULTIFACETED, SUSTAINABLE PRIMARY AND COMMUNITY-BASED HEALTHCARE SOLUTIONS.
“THE OVERALL RATES OF MYOCARDITIS PER 100 000 DOSES WERE STILL VERY LOW FOR BOTH VACCINE PRODUCTS,”

A Umodelling study to explore optimal allocation of vaccines against monkeypox virus (MPXV) provides a road map for public health to maximize the impact of a limited supply of vaccines. The article, published in CMAJ (Canadian Medical Association Journal), confirms that prioritizing vaccines to larger networks with more initial infections and greater potential for spread is best.
“We hope that these insights can be applied by policy-makers across diverse and dynamic epidemic contexts across Canada and beyond to maximize infections averted early in an epidemic with limited vaccine supply,” says Dr. Sharmistha Mishra, MAP Centre for Urban Health Solutions, Unity Health Toronto.
As of November 4, 2022, there were 1444 cases of MPXV in Canada, disproportionately among gay, bisexual and other men who have sex with men (GBMSM). A very limited supply of
smallpox vaccines is available and is being prioritized to populations experiencing disproportionate risks.
Researchers modelled two hypothetical cities as interconnected networks with a combined GBMSM community size of 100 000. The team then varied the characteristics of the two cities across a range of plausible settings and simulated roll-out of 5000
vaccine doses shortly after the first detected case of MPXV.
They found that the strongest factors for optimal vaccine allocation between the cities were the relative reproduction number (epidemic potential) in each city, share of initial cases, and city (or network) size. If a larger city had greater epidemic potential and most of the initial cases, it was best to allocate the majority of vaccines to that city. The team varied the reproduction number with a single parameter, but they highlight how many factors could influence local epidemic potential, including the density and characteristics of the sexual network, access to prevention and care, and the underlying social and structural contexts that shape both sexual networks and access.
“Under our modelling assumptions, we found that vaccines could generally avert more infections when prioritized to a larger network, a network with more initial infections and a network
with greater epidemic potential,” writes Jesse Knight, lead author and PhD candidate at the University of Toronto and MAP Centre for Urban Health Solutions, Unity Health Toronto. “Our findings further highlight the importance of global vaccine equity in responding to outbreaks, and also in preventing them in the first place,” he says.
The study emphasizes the interconnectedness of regions and that a population-level perspective is necessary.
“Strategic prioritization of a limited vaccine supply by network-level risk factors can maximize infections averted over short time horizons in the context of an emerging epidemic, such as the current global MPXV outbreak,” conclude the authors.
“Maximizing the impact of limited vaccine supply under different early epidemic conditions: a 2-city modelling analysis of monkeypox virus transmission among men who have sex with men” is published November 28, 2022 ■ H
niversity of Saskatchewan (USask) researchers have developed a new method of killing brain cancer cells while preserving the delicate tissue around it. The technique also has a remarkable side-benefit: making chemotherapy treatment of brain cancer suddenly possible.
The technique involves placing long needles through the skull and sending pulses of electrical current into a glioblastoma tumour – the pernicious variety of brain cancer that caused Tragically Hip frontman Gord Downie’s death.
“A safer and more effective cancer treatment may be clinically possible,” said Dr. Mike Moser (MD), USask College of Medicine general surgery researcher and co-author of a study published recently in the Journal of Biomechanical Engineering.
“Patients with brain tumours may now have another option for local treatment that does not involve opening the skull, and does not involve heat or radiation.”
The USask-led research team created 3D models of cells to test which treatment protocols of electrical current – called irreversible electroporation (IRE or NanoKnife) and high-frequency irreversible electroporation (H-FIRE) – can destroy glioblastoma cells while minimizing the risk to surrounding tissues and blood vessels.
Glioblastoma, the most aggressive and deadly form of brain cancer, affects one in 25,000 Canadians, and only six per cent of those with the cancer currently survive longer than five years after diagnosis.
The technique relies on how glioblastoma cells respond to the electrical current. The researchers discov-
ered tumour cells can be killed with a smaller electrical field than would kill surrounding healthy tissues.
They also discovered that this technique temporarily disrupts the blood-brain-barrier – the semi-permeable membrane that allows only tiny molecules to pass from the blood into the brain.
“The blood-brain barrier prevents many treatment drugs from getting to the tumour,” said USask biomedical engineering researcher Dr. Chris Zhang (PhD), co-author on the study. “We’ve shown that our technique can also help to open this barrier, so the brain is better able to receive other treatments – like chemotherapy or drugs that help increase the immune response – and help the patient fight the tumour in a systematic manner.”

The team also involved USask doctoral student Lujia Ding, and post-doctoral fellow Dr. Zheng Feng (PhD), as
well as researchers from China’s Fudan University and Shanghai University. The project is part of an extended collaboration with Dr. Bing Zhang (PhD), a former USask doctoral student of Moser and Zhang.
The research was funded by CREATE and Discovery Grants from Canada’s Natural Sciences and Engineering Research Council, a grant from the Royal University Hospital Foundation, and a grant from National Natural Science Foundation of China to Dr. Bing Zhang and his team.
The next step in the research is to develop a combined method of tumour removal and immunotherapy using their H-FIRE technique. ■ H

The COVID-19 pandemic and the increased use of virtual care have intensified the calls for timely and accurate data sharing in Canada. We can answer the calls by taking a collaborative pan-Canadian approach to secure data sharing in a digital environment that empowers patients and clinicians while protecting patient information.
Canada Health Infoway (Infoway) recently published a white paper called A Path Forward for Data Sharing In Canada that champions this approach, and makes it clear that privacy is NOT a barrier to data sharing. The white paper was developed through a literature review, key reports published during the pandemic, and consultations with stakeholders including privacy commissioners and privacy leaders, clinicians, patients and health technology providers. Many of these stakeholders are living and breathing the challenges of data sharing every day, so it’s vital that their voices be heard.
The observations and recommendations in the paper are based on these underlying principles:
enables better health care for patients and improves the overall Canadian health care system;
sharing among their providers; creased control over their health data; and dictions is desirable because it benefits all Canadians.
The rapid adoption of virtual care during the early months of the pandemic put a stark focus on the privacy controls and processes around the sharing of health data. As one privacy leader who participated in our consultations put it, “all the tiny gaps in the systems got highlighted.” From
to clearly articulate the barriers and challenges, identify opportunities, and propose solutions.
The barriers and challenges fall into these categories:
guidance and education on permissible uses and disclosures of data is unclear;










































lative roles of the parties, which is a key enabler to setting efficient rules for collections, uses and disclosures;
participants in a data system share the decision-making around data) is not well-understood, making the obligations of each party unclear. This impedes timely implementation of these kinds of arrangements and sharing agreements; risks of protecting personal health between data custodians and service providers and may create a discrepancy between assumption and ability to mitigate risk; provided to custodians and this gap can result in fear of penalties for unauthorized disclosure/sharing;
sharing agreements and resources to support data sharing; and
can and should share in protecting and enabling data sharing is unclear.
The white paper goes into much greater detail about each category, so I’ll focus now on the opportunities we’ve identified and the solutions we propose.
There is a need for clear frameworks and standards for health technology providers and custodians that provide greater clarity about how to abide by privacy and security best practices
will support practical and enforceable measures to enable a common “language for everyone to speak” and a common set of rules to follow, and will help establish trust.

We need to move from considering only custodianship, and toward embracing a model of information stewardship. This shift in perspective will give clinicians access to the data they need to provide care, while retaining
curity of the data, and it could enable patients to have more meaningful ac-

We need to take opportunities to modernize our data governance legislation to consistently put patients at the centre. We should also continue to embed

data sharing within privacy legis-








lation including considering where health technology providers may play a key role in ensuring data protection.
There are also benefits to be gained from data literacy education, including privacy education, for patients, as well as privacy training and education for health technology providers and custodians. This raises awareness of the
cy over their data, and ensure that all
enable important data sharing.
As I mentioned at the outset, the path forward for data sharing
pan-Canadian approach. Infoway and our partners and stakeholders have already made strides in some areas, such as national procurement of virtual care solutions, a digital health literacy program for Canadians, and the creation of a pan-Canadian interoper-
There is much more work to be done, so we hope this discussion leads to continued and growing collaboration and, most importantly, concrete action. H
Despite extensive scientific research and policy developments, urgent coordinated action is needed to tackle the growing threat of antimicrobial resistance (AMR), often referred to as a the next (silent) pandemic
AMR occurs when antimicrobials are no longer effective against the microorganisms they were designed for, leaving no treatment options to fight infections. AMR occurs naturally as microorganisms like bacteria, viruses, fungi, and parasites change or adapt over time, either by modifying the target of the antimicrobial, or by developing and exchanging resistance. The overuse and misuse of antibiotics in humans, animals and plants is speeding up this process

Some of the factors contributing to the spread of AMR globally include:
• The use of antibiotics in agriculture, veterinary medicine and food production
• Poor infection prevention and control practices
• Non-optimal use of diagnostic tools for rapid and reliable detection of pathogens and resistance
• Access barriers for efficacious vaccines

• Lack of antibiotics to treat infections caused by multidrug resistant bacteria

• Weakness or absence of surveillance programs to track localized cases of AMR
• Absence of a global, uniform and coordinated response between all countries
• Globalization as the population, animals and food products travel more, spreading resistance more quickly and easily between countries and continents
But scientific experts highlight the main reason for the spread of AMR is overuse and misuse of antibiotics.
It is estimated that more than 5,400 Canadians die every year from infections caused by bacteria that have become resistant to antibiotics. Worldwide, AMR is linked to close to five million annual deaths, more than HIV/AIDS, malaria, or breast cancer.
According to a quantitative model developed for the Council of Canadian Academies using existing data, a panel of experts found that in Canada, 26 per cent of infections are resistant to the drugs generally used to treat them. The same report also states that by
2050, resistance rates are likely to rise to 40 per cent which could result in the loss of 15 Canadian lives daily and $396 billion in gross domestic product (GPD).
AMR has been recognized as a global emergency by the World Health Organization (WHO), Centers for Disease Control, and was discussed at the 17th G20 Heads of State and Government Summit in Bali, Indonesia. International policy bodies and governments have added AMR near the top of their political agenda and have been calling for more research and action plans.
The cost of AMR to national economies and their health systems is significant as it affects the productivity of patients and their caregivers due to prolonged hospital stays and the need for more expensive and intensive care. Without effective tools for prevention, adequate treatment of drug-resistant infections, and access to existing and new quality-assured antimicrobials, the number of people failing treatment or dying from infections will increase.
A major part in the strategic reduction of AMR lies with diagnostic devices that can inform and support clinical decision-making. This helps ensure that the right antibiotic treatment
(dosage and duration) is given to the right patient for the right condition. In particular, new syndromic diagnostic technologies allow microbiology labs to provide this information faster and more accurately than ever before.
The pandemic has shown Canadians the importance of these and several modern, fast, innovative devices that have been deployed by the federal government. This allowed people to get tested close to home, in their area.
Diagnostic tests can play a major role for the optimal diagnosis of an individual, for the optimal and cost-effective functioning of health systems and for the benefit of the general public.
In fact, already in the early 2000s, research developments were underway to transform in vitro diagnostics from central laboratory to ‘near patient’ or ‘at bedside’. We are at the cusp of seeing such testing available in Canada, extending beyond clinical biochemistry (e.g. glucose monitoring for diabetes mellitus) to other pathology disciplines, including microbiology and hematology.
AMR is an ongoing and growing problem affecting Canada in several ways. While it is important to look at what we already know and what has been done thus far, we can now look forward to how diagnostic stewardship and near-patient testing will help in the fight against AMR. ■ H
Samsung has become a global leader across various industries over the last 85 years, propelled by the drive for unmatched quality, supply resilience and innovation. Having that drive rooted in Samsung DNA, Samsung Bioepis is expanding its presence in the biopharmaceutical sector with an aim to improve access to healthcare.
Established in 2012, Samsung Bioepis is a biopharmaceutical company dedicated to unlocking the potential of biosimilars, and is committed to improving the accessibility of treatments for patients around the world. Our mission is reflected in our name – it is taken from the Greek words ‘bio’ meaning life, and ‘episteme’ meaning science.
A decade ago, although biosimilars were not known to many, we decided to develop biosimilars as we believed biosimilars could bring value to patients, healthcare professionals, payers and many other stakeholders within the wider healthcare system by increasing access to biologic medicines.
Biosimilars are biologic medicines that are highly similar to an already approved biologic drug, known as the reference biologic drug. There are no expected clinically meaningful differences in efficacy and safety between a biosimilar and the reference product authorized for sale, according to Health Canada.i
Within just a decade, Samsung Bioepis has become one of the major players in the global biopharmaceuticals sector, achieving this by expansively developing our biosimilars portfolio in a range of therapeutic areas including immunology, oncology, ophthalmology, hematology and endocrinology.
We use a data-driven approach and rigorous quality control in its biosimilar
development processes – from the preclinical stage to large-scale manufacturing – to produce cost-effective medication in a shorter period of time, or what we call it as ‘process innovation’.
By focusing on process innovation and establishing strong partnerships, Samsung Bioepis has six biosimilars that are authorized for sale and are available around the world.

Our innovative research and development platforms, combined with manufacturing and partnerships have helped us to establish a global footprint, so we can provide biosimilars to those who need them most.
Through global commercialization partnerships, we have extended our sales and marketing network to broaden the availability of our biosimilars to patients around the world.
In Canada, we have commercialization partnership with Organon, who have been working tirelessly with local physicians, pharmacists, and regulators to bringing quality medicine to
Canadian patients. For our ophthalmology biosimilar portfolio in Canada, we have commercialization partnership with Biogen.
Having similar safety and efficacy as reference biologic drugs and meeting the same rigorous regulatory standards, biosimilars have been authorized for sale in Canada since 2009.ii
Increasing the use of biosimilars authorized for sale by Health Canada would not only allow increased access and choice, but also bring medicines at more affordable costs to the Canadian healthcare system.iii iv Savings from biosimilars can support creating a more sustainable, cost-effective way to treat patients.v
Samsung Bioepis emphasizes the importance of making sure its products are delivered on time, so that patients can receive treatments at the right time. Supply chain and product continuity are the most important aspects of its mission, and it has made a promise to its patients that it will deliver medicines.
By having geographically diversified manufacturing and storage sites across three continents – North America, Europe and Asia, this “near-market” strategy gives us an edge that allows us to remain vigilant and respond quickly to market dynamics.
At the core of our business and vision are the patients around world without viable treatment options. This is why we are further committed to fulfilling our social responsibility and becoming a sustainable company, which is also a part of Samsung Philosophydevoting one’s talent and technology to creating products and services that contribute to a better global society.
As a biopharmaceutical company, we will continuously build our profile and presence in Canada and elsewhere around the world, while educating prescribers, patients and other stakeholders on the benefits that biosimilars can provide to the healthcare system.
Samsung Bioepis’s work remains far from finished. H
i Health Canada, Biosimilar biologic drugs in Canada: Fact Sheet, https://www.canada.ca/en/health-canada/services/drugs-health-products/biologics-radiopharmaceuticalsgenetic-therapies/applications-submissions/guidance-documents/fact-sheet-biosimilars.html
ii Patented Medicine Prices Review Board, Biologics in Canada. Part 1: Market Trends, 2018 https://www.canada.ca/en/patented-medicine-prices-review/services/reportsstudies/biologics-part1-market-trends.html
iii Canadian Agency for Drugs and Technologies in Health, Biosimilar Drugs https://www.cadth.ca/sites/default/files/pdf/biosimilar_drugs_patient_en.pdf
iv Biosimilars Canada, The Benefits of Biosimilar Medicines https://biosimilarscanada.ca/wp-content/uploads/2020/12/Module5_final_EN.pdf
v Patented Medicine Prices Review Board, Biologics in Canada. Part 2: Biosimilar Savings, 2018 https://www.canada.ca/content/dam/pmprb-cepmb/documents/reports-andstudies/chartbooks/biologics-part2-biosimilar-savings2018.pdf
COVID-19 and the current waves of seasonal flu and respiratory syncytial virus (RSV) are raising serious questions about whether and how our health-care systems can provide essential resources during times of crisis and beyond.
At Lakeridge Health, we believe that answers can be found in more and better health system integration – connecting all services, from primary care to hospitals to long-term care – so they work together as one.
Integration is no longer an option. It is a necessity. Our focus is on quality. We’re working hard to connect all health-care providers around a common purpose, so patients can expect the same high standard of care wherever and whenever they use the system.
The drive to integrate, and the logic behind it, is captured in Lakeridge Health’s vision: One System. Best Health.
COVID-19 and other viral illnesses have been putting this vision to the test.
Lakeridge Health, based in Durham Region, has been pursuing a strategy of health system integration. Our organization is one of Ontario’s largest health-care systems, with five hospitals and a sixth in the proposal stages, a long-term care (LTC) home, and one of the Region’s largest mental health providers., We are working closely with the Durham Ontario Health Team (OHT) to build partnerships with primary and community care providers. We have invested in a clinical information system connecting all hospitals across the broader Central East Region, providing a unified digital health platform for all patients.
When the pandemic arrived in early 2020, Lakeridge Health became the centre for infection control expertise, supplying resources such as personal
 Davis
Davis
protective equipment to community-based providers and LTC homes, and the centre of advanced clinical care, treating close to 5,000 seriously ill COVID-19 patients.
During one of the most intense waves of COVID-19, in partnership with the Durham OHT, we extended an urgent call to action to primary and community care partners. Within 24 hours, more than 250 recipients met virtually to offer help. Clinics across the region provided COVID-19 assessments and care options, easing the burden on our emergency departments. Clinicians staffed a virtual urgent care clinic serving thousands of patients.
Regional coordination among hospitals, public health, primary care, community clinics, and emergency responders enabled one of Ontario’s fastest vaccine rollouts. More than one million doses of COVID-19 vac-

cines were administered by November 30, 2021.
A COVID-19 Therapeutic Clinic, working with primary care and assessment centres, prescribed close to 20 percent of Ontario’s initial supply of the novel therapeutic Paxlovid.
Overall, the system responded quickly and effectively to the pandemic. When we rallied around a common purpose and understood our common goals, we were able to be successful.
But challenges remain.
Nurses and other frontline workers have been carrying the greatest burden of crisis response. Some are leaving for less stressful positions or leaving health care entirely. Those remaining face even more pressure, working extra shifts and caring for more patients. Other professionals and non-clinical staff have been stepping in where they can, so everyone in health care is feeling the added stress.
Staff shortages have caused temporary emergency department and acute care closures across Canada. Lakeridge Health is no exception, and we made the difficult decision to close an intensive care unit at one of our hospitals in the summer of 2022.
Health system integration is being tested again as severe respiratory illnesses place even more strain on resources. But there are early signs that it’s still the right approach.
Health-care professionals leave public systems because they aren’t getting what they need as employees. This includes better compensation, and extends to the full range of employee supports.
As a large system, Lakeridge Health can recruit centrally, offering diverse career opportunities across multiple hospitals and care centres. With a team of more than 8,000 staff and physicians, we have more capacity to support succession planning, education, mentoring, and health and wellness, along with innovations that enable efficiency, productivity, and teamwork. Integrated systems will be better positioned to put these supports in place.
All of this takes time and commitment. Building a fully integrated, sustainable health system is a journey, and much more work needs to be done.
But the benefits are important and achievable. The current challenges will hopefully prompt lasting changes that strengthen partnerships and collaboration, and substantial investments in the supports needed for health-care professionals to confront new challenges while living healthy, balanced lives.
Now, almost three years since the start of the COVID-19 pandemic, our health-care workers are not looking for praise or accolades for their courage and hard work during the crisis. They want the system-wide changes that will enable them to do what they do best – deliver excellent patient care. ■ H


Pfizer Hospital is committed to working alongside the healthcare community with the goal of helping build a resilient healthcare system.
Our goal is to look at holistic solutions that benefit all stakeholders, but most importantly patients.
We suggest focusing on:
1 Value-based healthcare decision making 2 Awarding products to multiple suppliers 3 Engaging in dialogue to incorporate transparency and reasonable discussions on terms and conditions
Pfizer remains committed to providing injectable medicines to the healthcare providers and patients that rely on these medicines by:
Investing in people, infrastructure,and expertise

Advocating for reasonable changes to the current procurement practices with the goal of fostering an equitable and resilient market
Contact your Hospital Strategic Healthcare Partner for more information

 By Dr. Frank Martino and Tiziana Rivera
By Dr. Frank Martino and Tiziana Rivera
In 2019, William Osler Health System (Osler) embarked on a transformational quality and patient safety journey aligned with its strategic focus on quality excellence. Embracing a visionary and purposeful approach, Osler developed a more robust corporate quality infrastructure that reaffirmed accountability for quality and patient safety at the individual, program, corporate and governance levels of the organization. Osler has been proactively working to instill a long-term best practice mindset across the organization.
In the two years that followed, Osler found itself facing the stark realities of the COVID-19 pandemic as its hospitals tested, vaccinated and treated people in one the hardest hit communities in Ontario. Discussions about quality and patient safety took on a heightened urgency, accelerating the implementation of strategic initiatives that would equip teams to continue to deliver safe, quality care under incredibly challenging circumstances.
Among the most significant of those initiatives was the roll-out of digitally-driven iHuddle Boards in late 2020 to transform how Osler’s clinical teams manage quality and safety, review unit/program performance, and collaborate on key organizational initiatives. The large digital touchscreens in each unit are designed to visually translate Osler’s corporate strategic directions in a manner that is as meaningful to frontline teams as it is to the executive team and Board. They enable senior leaders to share strategic, operational, and quality metrics with clinical units in real-time, so that everyone is working with the same data to enable evidence-informed decision-making at both the unit level and organization-wide.
When Accreditation Canada surveyors visited Osler in 2021 and 2022, they identified the iHuddle Boards as an organizational strength, recogniz-

ing their effectiveness in supporting staff and physician communication, collaboration, engagement and quality improvement, particularly in reinforcing the integration of required organizational practices (ROPs) into daily work. Through a separate evaluation process, the iHuddle Boards and process were recognized as a global leading practice by the Health Standards Organization (HSO) and Accreditation Canada.
Osler’s pursuit of quality excellence was further strengthened in November 2021, when Osler began a three-year journey to become a globally recognized Best Practice Spotlight Organization (BPSO) thanks to a partnership with the Registered Nurses Association of Ontario (RNAO). Osler’s journey to achieve BPSO designation signifies its long-term commitment to deliver the highest standards of care to patients. Among the evidence-based best practice guidelines that nursing and interprofessional teams are working to implement is Preventing Falls & Reducing Injury from Falls, which is the number one patient safety incident reported through Osler’s PSIM Framework.
During the pandemic, Osler also initiated a standardized, team-based approach to patient safety incident management (PSIM) to improve reporting, staff, physician, patient and family engagement and response to patient safety incidents. Implementation of the PSIM Framework has led to enhanced corporate oversight for incident management, greater staff, physician and patient engagement in the process, a significant increase in the reporting of incidents, and an increase in the number of reports for incident types that had been historically underreported. The PSIM Framework is a testament to staff, physicians, leaders, and Osler’s Patient and Family Advisory Council members who collaborated to co-create a non-punitive, evidence-based and inclusive approach to patient safety incident reporting.

With their resilience put to the test on multiple fronts throughout the pandemic, Osler’s staff and physicians have not only succeeded in sustaining quality and patient safety standards during this time – in many cases they have exceeded them. That was borne out in 2022, during which time Osler earned Accreditation Canada’s highest rating, the Accredited with Exemplary Standing designation; was nationally acknowledged by the Canadian College of Health Leaders (CCHL) as the recipient of the prestigious 2022 Excellence in Patient Safety Award for its approach to patient safety incident management; and was recognized by the Health Standards Organization (HSO) and Accreditation Canada for five global leading practices that improve quality and patients’ lives.
Building on a strong history of supporting physician and clinician training, Osler is working as the primary hospital partner with Toronto Metropolitan University to develop

a School of Medicine in Brampton. This represents a significant opportunity to teach and train home-grown talent and strengthen health human resources capacity across the region. This will also create new opportunities to expand Osler’s clinical and applied research program through academic and clinical partnerships that support Osler’s evolution into an academic health centre.
In a year in which Osler marked the 50th Anniversary of Etobicoke General Hospital, the 15th Anniversary of Brampton Civic Hospital, and the 5th Anniversary of Peel Memorial Centre for Integrated Health and Wellness, it is proud to build on the rich legacies of the teams that came before. Looking ahead, Osler will continue to embrace transformative thinking and a best practice mindset to ensure the further advancement of its commitment to quality so that the community continues to receive safe, quality, compassionate care now and into the future. ■ H
Getting the full picture from your medical imaging is critical to patient care. That’s why LG Medical Displays use the latest innovations to help medical professionals easily distinguish even delicate details with accuracy and Learn more about all the details that go into an LG Medical Display and request a demo at: lg.com/ca_en/business/digital-showroom/medical-display













 By Ananth Ravi
By Ananth Ravi
The ongoing effects of the COVID-19 pandemic continue to overwhelm Canada’s healthcare system. The surgical backlog that has built up in our hospitals since 2020 continues to come at a cost for patients and their families. In Ontario alone, hospitals this past spring were facing a backlog of one million surgeries and the province’s doctors are now pushing for innovative and efficient solutions, such as non-profit surgical centres in the face of this challenge.
We’ve always known that delays in care can have life-or-death consequences for patients – particularly for people living with cancer. The Canadian Cancer Society has noted that delaying cancer care by just a few weeks can increase the risk of death by around 10 percent. Leaving COVID aside – even other respiratory challenges such as RSV and the seasonal flu can push wait times over the top in an already-strained system.
One way to help solve the backlog for Canada’s overloaded hospitals is to adopt newer and better technology that can help make surgeries more efficient while improving the patient experience.
For example, many hospitals still use wire-guided localization, a way to mark the location of a lesion before surgery, by inserting wires into the patient’s breast. It’s a technique that hasn’t changed much in 50 years. Wire-guided localization demands a lot of coordination among the patient, radiologist, surgeon and pathologist because the procedure has to be performed on the same day as the surgery. This can create scheduling challenges for all the people involved as well as for the hospital itself.
Wire-guided localization is particularly challenging and anxiety-inducing for patients. Because the lesion has to be marked on the same day as the surgery, it can mean a long day spent waiting at the hospital. As part of the wire-guided procedure, the patient
needs to fast the whole time, which can sometimes lead to fainting. Patients often need to sit around in a hospital gown as they wait for an operating room to open up, while also trying to avoid accidentally snagging their gown on the protruding wire. Finally, the wire has also been known to become displaced or transected during surgery, which can lead to inaccuracy and additional procedures.
Instead of relying on this method, hospitals should consider a technology where the marker can be implanted without wires on the same day or a few days before surgery as a way to ease backlogs in a way that is much more patient-centred and efficient.
One such technology is MOLLI Surgical’s Health Canada-approved MOLLI®, a precise, easy to use new technology for soft tissue localization. Recognized with a gold medal in the 2022 Medical Design Excellence Awards, named as one of TIME Magazine’s Best Inventions of 2022 and one

of the Next Big Things in Tech by Fast Company, MOLLI puts the patient first by providing a better experience over traditional wire and other localization options. The wire-free technology includes the MOLLI Marker®, which is detected using the MOLLI Wand®. The MOLLI Tablet® then displays the distance between the tip of the MOLLI Wand and the MOLLI Marker, helping surgeons locate lesions (and precisely remove) them more efficiently with improved accuracy. The localization procedure takes about five minutes. This gives patients autonomy over their scheduling and creates flexibility for health systems to adapt quickly to changing needs.
From a hospital perspective, wirefree technology allows for a more flexible approach when it comes to scheduling surgeries, reduces the impact of unforeseen delays in radiology, and increases the number of surgeries that can be performed in a day. Just by “decoupling” localization from sur-
gery, care teams can improve their workflows to make care for patients more timely and create a better overall experience. When hospitals take this step, it leads to a 34% increase in the scheduling capacity of radiology departments and a 41% increase in breast-conserving surgery programs. In short, wire-free localization provides a better experience before, during, and after surgery for patients, for the radiologist who helps to locate the lesion, and for the surgeon who has to remove it.
For people who work in hospitals, improving their workflows, clearing cancer surgery backlogs and making sure people can continue to have faith in their local hospital are all vital concerns. As hospitals and administrators explore new ways to increase efficiency in the face of these wait-time challenges, it’s important that the changes that are ultimately adopted are not just efficient for the hospitals, but centred on the patient, too. ■ H
Atool that Emergency Department clinicians can use to guide hospital admission or discharge decisions for heart failure patients reduces 30-day all-cause death or cardiovascular hospitalization by 12 per cent, according to a new trial from the Peter Munk Cardiac Centre (PMCC) at University Health Network (UHN), ICES, and the Ted Rogers Centre for Heart Research.
The validated tool, which was developed using data analytics, helps hospital staff to ascertain whether heart failure patients fall into low-, intermediate-, or high-risk categories, which can then inform the decision to admit a patient to hospital or discharge with follow-up care.

The randomized trial, published in the New England Journal of Medicine, included 10 hospitals and 5,452 patients in Ontario, Canada, and assigned
hospitals to usual care (when clinicians use their clinical judgement to guide decisions) followed by a cross-over to the use of the tool. The study was made possible through funding from the Ontario SPOR SUPPORT Unit (OSSU).
The study comes as hospitals grapple with overcrowding and staffing shortages and suggests that heart failure patients at lower risk of adverse events can be discharged from the Emergency Department or following a short hospital stay – with rapid follow-up care in place.
“Heart failure places a substantial health burden on patients and increases healthcare utilization and costs,” says lead author Dr. Douglas Lee, staff cardiologist at the Peter Munk Cardiac Centre at UHN, Ted Rogers Chair in Heart Function Outcomes at the Ted Rogers Centre for Heart Research (TRCHR), and Senior Scientist at ICES. “We need new approaches to
improve the care that we deliver to patients with heart failure who come to the Emergency Department, and the strategy that we tested may be a step toward achieving this goal.”
The tool is used to support clinicians’ decision-making about who should be hospitalized and who can be discharged home early, with provision of a rapid follow-up visit at a clinic staffed by a nurse and supervised by a cardiologist.
Researchers found that the hospital-based strategy for decision support was associated with:
• A 12 per cent reduction in the rate of all-cause death or cardiovascular hospitalization over 30 days.
• A decrease in the rate death or cardiovascular hospitalization over a 20-month follow-up.
• Fewer than six deaths or all-cause hospitalizations for low-risk and intermediate-risk patients who were
discharged from hospital until they could be seen by a doctor in the outpatient clinic.
“It has always been our goal to ensure that we provide the right care, for the right patient, at the right time,” says senior author Dr. Heather Ross, Scientific Lead, Ted Rogers Centre for Heart Research, and Division Head, Cardiology, at the Peter Munk Cardiac Centre at the University Health Network. “This diagnostic tool will have an immense impact, not just on patients and families, but on the whole of the healthcare system.”
The study, “Trial of an Intervention to Improve Acute Heart Failure Outcomes” was published in the New England Journal of Medicine. The study was supported by ICES and was funded by the Ontario SPOR Support Unit, the Ted Rogers Centre for Heart Research, and the Canadian Institutes of Health Research. ■ H
Learn about the findings: infoway-inforoute.ca/en/connected-care
We’ve gathered evidence about the current state of digital health interoperability in Canada and the significant opportunities for health system improvement.
2022 Canadian Interoperability Landscape StudyThis article was provided by UHN News.
On November 16th, St. Michael’s Foundation aired its 8th annual medical research competition, Angels Den, and awarded St. Michael’s Hospital teams $500,000 to fund their research.
“Angels Den has provided critical seed funding to launch several homegrown innovations that promise to revolutionize areas of medicine,” said Dr. Ori Rotstein, Vice President, Research and Innovation, at St. Michael’s Hospital. “It’s the catalyst for getting early-stage research projects by some of the best minds in medicine off the ground.”
During the hour-long virtual event that streamed on angelsden.ca, six teams of scientists pitched their research ideas to a panel of celebrity judges and more than 60 jurors for a chance to win the Keenan Award for Medical Discovery or the Odette Award for Health System Innovation, each valued at $150,000. A third award, the $100,000 Canada Life People’s Choice Award, was handed out to the team that received the most viewer votes. The four finalists that did not win either the Keenan Award or the Odette Award were awarded $25,000 for their projects.
The Keenan Award for Medical Discovery funds novel therapies, better diagnostics, vaccines or medical devices that will improve patients’ lives.
• Dr. Monica Farcas, Investigator, Li Ka Shing Knowledge Institute, Surgeon-Entrepreneur, Urologist, St. Michael’s Hospital.
• The Challenge: The pain of kidney stones is excruciating and 10 percent of adults have an attack in
their lifetime. While surgeons can remove kidney stones by breaking them with lasers, the process leaves tiny fragments, like sand, that can create new stones over time. With too many recurrences, people can lose their kidney function altogether.
• The Solution: Dr. Monica Farcas has invented a device that sucks up the kidney stone fragments during surgery leaving the patient completely stone free. Now they want to take the prototype to the next level. For the patient, the innovation means healthy kidneys and a pain-free life. And for the health-care system, it means fewer emergency visits and operations.
The Odette Award for Health System
Innovation aims to improve the healthcare system’s effectiveness, efficiency, equitability or sustainability.


• Dr. Laurent Brochard, Clinician Scientist, Keenan Research Centre for Biomedical Science, Keenan Chair in Critical Care and Acute Respiratory Failure, and Intensive Care Physician, St. Michael’s Hospital

• Dr. Muhammad Mamdani, Scientist, Li Ka Shing Knowledge In-
stitute and Vice President, Data Science and Advanced Analytics, and Odette Chair in Advanced Analytics, St. Michael’s Hospital.
• The Challenge: Mechanical ventilation saves lives. But if it’s not matched to each patient, it can further damage lungs, cause anxiety, pain and discomfort, and even injure other organs. For too many patients, that can mean prolonged stays in hospital, and lead to longterm disability or even death. Not surprisingly, each patient needs different levels of ventilation. How can clinicians make sure a patient gets the full benefit of mechanical ventilation, with none of its bad effects?

• The Solution: Dr. Laurent Brochard and Dr. Muhammad Mamdani will create and deploy into practice AI algorithms that analyze a patient’s status, minute-by-minute. The clinicians then use this information to adjust the ventilation based on patients’ real-time needs which results in less sedation, fewer complications and deaths, and quicker recovery. And for hospitals, that means ICU beds are freed up faster to care for other critically ill patients.
The Canada Life People’s Choice Award goes to the online audience favourite, based on the number of their votes.
• Dr. Carmen McCaffrey, Investigator, Li Ka Shing Knowledge Institute, Minimally Invasive Gynecologic Surgeon, St. Michael’s Hospital
• Dr. Elizabeth Miazga, Clinical Fellow, Minimally Invasive Gynecologic Surgery, St. Michael’s Hospital.

• The Challenge: Endometriosis is an agonizing pelvic disease that afflicts 10 per cent of women and people assigned female at birth. Diagnosis is often delayed by 5-10 years and surgery may take years to book, leaving women to suffer with chronic pain, infertility, and significantly impaired quality of life. First-line treatments, like mindfulness and pelvic floor physiotherapy, are effective but often not accessible. They can be too costly for some, since they’re not covered by OHIP, and providers are few and far between.
• The Solution: Dr. Carmen McCaffrey and Dr. Elizabeth Miazga have already developed a basic MyEndo app, which hosts a mindfulness course for patients with endometriosis that eases pain. Now they want to expand the app to include a wide range of online treatments and educational resources, making it free and open access, so women everywhere can get the care they desperately need and deserve.
The episode can be viewed online at angelsden.ca. ■ H

















GetReady® is a digital patient management solution that enables hospitals and clinics to remotely manage their patients and provide personalized procedure preparation, follow-up care, and monitoring — including risk monitoring for waitlisted patients — from the comfort of the patient’s home.
Learn more at medtronic.ca/GetReady
© 2022 Medtronic.
As semblances of normalcy gradually return following the COVID-19 pandemic, lingering effects related to attrition, burnout, and stress continue to drastically impact the healthcare system. The Bureau of Labor Statistics observed a loss of 524,000 U.S. healthcare workers from February 2020 to September 2021, bringing the healthcare infrastructure to the verge of collapse. The situation is similar in Canada. Making matters worse is new research from Elsevier Health that spans over 109 countries and that continents which indicates that a further third of professionals intend to leave the field within the next two to three years. This substantial loss in healthcare’s human resource is a worldwide issue that has forced the industry to think of new solutions that minimize labor shortage disruptions and does not come at the cost of patient care quality. In making pivots to the way healthcare operates, Telemedicine has so far proved itself to be a major player in healthcare reform.
Telemedicine, described as virtual treatment of patients through audiovisual technology, increases staff workflow efficiency, enables easier patient access to services, and allows

for a reduction in healthcare related costs for both patients and clinicians. The future of Telemedicine is one which allows healthcare professionals to see patients across clinics, cities, and provinces/states in the same day without any physical displacement of caregiver or patient. However, there is still a technology gap for healthcare services that require patient contact. Noticing the healthcare reconceptualization that is currently underway, some companies have attempted to augment this solution through innovations within the Telemedicine realm.
For instance, Wosler Corporation, a Canadian healthcare technology company is currently building a telemedicine platform of virtual healthcare labor, digitized clinics and inter-

connected robotic devices that would allow sonographers to conduct remote ultrasound scans of patients.


Wosler Corporation has already achieved a major milestone that showcases the wide-ranging potential of Telemedicine. Within the last month, Wosler Corporation conducted a fully virtual ultrasound scan by stationing a sonographer in London, Ontario with a remote-controlled device that preformed a scan 3500 km away in Wabasca, Alberta. Wosler Corporation’s aim, which is centered on improving the distribution of scarce human resources in healthcare, also expands into the artificial intelligence realm by its vision of relegating low-grade work to artificial intelligence programs. This would permit healthcare profes-
sionals to address more pressing issues when on the clock and allow for less distraction to be directed toward administrative aspects (e.g., data entry, triaging, etc.) Automation would allow the healthcare system to make a considerable shift in workflow productivity as many clinicians themselves are expecting to be relieved in this way. According to the aforementioned Elsevier Health international research survey, 56% of sampled doctors and nurses worldwide are expecting artificial intelligence support tools that will serve them in the bulk of their clinical decisions within the next decade.
Telemedicine also allows rural and remote areas to be served with far greater ease. Access to specialized medical services in these communities has been a long existing issue in healthcare, a problem that are not new to the healthcare field, making the future utility of Telemedicine likely ubiquitous. As a result, a strong case can made that the greatest indirect benefit that the pandemic left behind is the current evolution of the healthcare system. This evolution, expedited by companies like Wosler Corporation, will allow more patients to be seen, lessen the cost and burden on the healthcare system, and reduce several barriers related to access. ■ H

April 27-30, 2023 Montreal, QC
Gather with your radiology community at the Canadian Association of Radiologists’ Annual Scientific Meeting taking place April 27-30, 2023. Join us at our NEW location Le Westin Montréal, Montreal, QC. This year’s program, developed by the CAR 2023 Annual Scientific Meeting Planning Committee, focuses on technological innovation as a crucial element in the advancement of imaging care. This year’s event will offer sessions relevant to many different subspecialties and practice environments. CAR 2023 features engaging didactic lectures and interactive Q&A sessions with presenters, along with opportunities to network and socialize with colleagues. Speakers from across North America will come together to deliver captivating plenary lectures, including presentations from Dr. Jan Fritz (New York University), Dr. Jeremy Erasmus (University of Texas), Dr. Jorge Soto (Boston Medical Centre), Dr. Carlos Torres (University of Ottawa), and Dr. Yiming Gao (AIRP).
The CAR’s four Affiliate Societies are developing amazing educational sessions that highlight cardio-thoracic radiology (CSTR), abdominal radiology (CSAR), emergency and trauma radiology (CETARS), and pediatric radiology (CanSPR). The program will also feature two hands-on interactive workshops, one focused on MSK Ultrasound and one on advanced structured reporting. Back by popular demand is a dedicated virtual Trainee Day where medical students, residents, and fellows can participate in an entire day of sessions and lectures aimed at their educational needs.
CAR 2023 – Advancing Imaging Care Through Innovation is the premiere radiology event of the year and an experience not to be missed!
Radiology departments consist of a variety of overlapping and intersecting responsibilities, with tremendous interplay between disciplines. This can make managing the professional relationships between radiologists, technologists, booking clerks, nurses, and others a complex challenge.

Dr. Jean Seely is President of the Canadian Society of Breast imaging (CSBI) and Co-Chair of the CAR’s Breast Imaging Working Group. In her decades of experience, having positive interaction between these groups is critical to accomplishing departmental goals and offering better patient care, while strained relationships can drastically impede the aims of a department.






















“The ongoing challenge is simply that each different group within a ra-




diology department has different responsibilities or goals and processes for achieving them,” says Dr. Seely. “As radiologists, we know what is required of us to do our jobs but sometimes we might not see how our work fits within the larger network of clinical administration.”





Dr. Seely says that when speaking from different vantage points in a workplace, it is often difficult to understand the fundamentals of each other’s perspectives. These situations are often a matter of properly defining the problem, seeking first to understand it before resolving it. She recalled an experience implementing new workflow software as an example of this disconnect in action.





“When bringing in this new medical information system, what we didn’t initially realize was that the informa-



“We’ve found that the ease of using the MEDRAD® Centargo injection system is having a real impact on our technologists’ ability to do their work quickly and with less worry.



For example, because I am spending less time preparing the injector and its components, I have more time to spend with the patient, increasing their comfort level and understanding of the procedure. The quality of this interaction provides a better overall experience for both myself as a clinician and the patient.”

tion the radiologist sees is not necessarily the same as what the technologist or booking clerk might see on their end, which led to several communication problems. It wasn’t until we took screenshots and shared our exact viewpoints of the information that we fully understood what the other person was talking about.”

The inverse can also take place, and lead to positive outcomes with efficient execution.


Dr. Seely recounted an issue surrounding pre-surgical radioactive seed procedures. The underlying problem was that patients were consistently delayed getting from the pre-surgical procedure to the surgery appointment. This was difficult for patients, and surgeons were displeased with the slow downs. Despite carrying out the correct pre-surgical procedures, radiologists were being held accountable for the delays.

The issue brought together clinical and administrative staff to better un-
derstand each other’s role in the process, which swiftly generated a solution. “Once the manager found out the radioactive seed procedure could be done outside of the surgery day instead of same-day for similar or lower costs, administrative changes were implemented quickly to adjust the staffing needs and the delays were gone,” says Dr. Seely.
Though the outcome in this instance turned out positively, it did not come about on its own or accidentally, says Dr. Seely. Had radiologists, surgeons, and administration remained siloed and not come together to commonly understand each other, the solution for the delays may not have materialized or been implemented as quickly as it did.
“It is paramount that radiologists invest time in building relationships with people administering medical care,” says Dr. Seely. “It is an incredibly effective way of avoiding conflict and resolving problems.”
“AS RADIOLOGISTS, WE KNOW WHAT IS REQUIRED OF US TO DO OUR JOBS BUT SOMETIMES WE MIGHT NOT SEE HOW OUR WORK FITS WITHIN THE LARGER NETWORK OF CLINICAL ADMINISTRATION.”
– Mike Minoo, Manager, CT and Interventional Radiology at Sunnybrook Health Sciences Centre
24-hour use




























































Cordless mobility through a battery powered, Wi-Fi enabled configuration.































Touch screen within the scan room so that you can be close to your patient.





The bar code reader reduces manual data entry and provides easy traceability and access to contrast and injection details.*
















The simple snap-in patient line autoprimes upon insertion and is ready for the next patient in less than 20 seconds.




One click Centargo’s daily set-up process can be completed in under 2 minutes.
For more information, please visit radiology.bayer.ca * When combined with automated documentation software
edical imaging is a cornerstone of patient care in Canada. Throughout healthcare, medical imaging procedures are relied upon to identify, diagnose, and treat disease. When requiring imaging it is imperative that patients are receiving the right test at the right time, providing the most relevant clinical value to the patient through their journey.
The Canadian Association of Radiologists (CAR) is advocating for the implementation of national electronic referral systems incorporating Clinical Decision Support (CDS) tools for medical imaging, to ensure that patients receive more timely access to imaging. Integrating CDS tools into clinical workflows across the country would help patients receive the most suitable test based on their symptoms.
The goal of these systems is not only to help to reduce further backlogs for medical imaging but also provide support for referring practitioners in selecting the best imaging procedure for their patients.
The CAR with the support of the Canadian Medical Association and working with the Canadian Association of Emergency Physicians, the College of Family Physicians of Canada, the Nurse Practitioners Association of Canada, and the Society of Rural Physicians of Canada, have already embarked on a national project focused on the creation and integration of Canadian-specific diagnostic imaging referral guidelines into CDS systems. These evidence-based, peer-reviewed guidelines will be freely available to help guide healthcare professionals decision-making pro-
Grand River Hospital (GRH) and KA Imaging are partnering on an innovative commercialization project supported by the Coordinated Accessible National (CAN) Health Network. The Reveal 35C detector will be installed at the hospital and will help clinicians validate patient tube and line placements as well as monitor the health of patients to prevent respiratory conditions.
Recently, the Reveal 35C was evaluated by University Health Network (UHN) through the Early Adopter Health Network (EAHN™), a program developed by the Ontario Bioscience Innovation Organization (OBIO®). After a successful evaluation at UHN, KA Imaging’s device received a positive determination of value.
Reveal™ 35C is a single exposure, portable, digital dual-energy subtraction (DES) X-ray detector. Powered by its exclusive SpectralDR™ technology, it uses the same radiation dose as a chest X-ray to create 3 different images without motion artifacts. In medical applications, this means a regular DR, plus a soft tissue and bone images.
“The Reveal 35C is an opportunity for Canadian hospitals to improve care by producing images that offer extra information, relieving pressure in their emergency rooms and ICUs,” says Amol Karnick, President and CEO of KA Imaging.
cesses, enhance care and enable better communication among healthcare providers.
“Ensuring that patients receive the medical imaging referral that provides the most clinical value at the right time, while also reducing risks as much as possible is the goal,” said Dr. Ryan Margau, co-chair, CAR Imaging Referral Guidelines Working Group and chief and medical director, Medical Imaging, North York General Hospital. “Widespread adoption of CDS tools will allow for referring medical professionals to have access to latest evidence-based knowledge as part of their regular workflow – taking some of the unknowns out of ordering medical imaging.”
Canada is behind other industrialized countries when it comes to e-referrals underpinned by CDS. CDS systems for medical professionals referring to radiology have been implemented with considerable success in other countries. The Royal College of Radiologists in the United Kingdom has partnered with MedCurrent Corporation, a leading Canadian CDS software company, to incorporate the UK-focused radiological referral guidelines into a CDS software platform called MedCurrent iRefer CDS. This system provides UK clinicians with robust referral guidelines directly at the point-of-care.
Moreover, the National Health Service (NHS) in England has invested millions to deploy CDS throughout the country. Over the next few years, they will embark on a Digital Diagnostic Capability Program (DDCP) initiative to improve access to diagnostic services to English citizens.
In 2014, the United States Congress passed the Protecting Access to Medicare Act (PAMA) that requires referring providers to consult US-based referral criteria guidelines, in conjunction with approved CDS Systems, prior to ordering advanced diagnostic imaging services (CT, MR, Nuclear Medicine and PET) for Medicare and Medicaid patients.
While these developments have not gone unnoticed in Canada, only a few Canadian hospitals have started implementing CDS solutions. North York General Hospital, in Toronto, has implemented a MedCurrent iRefer CDS system that is integrated into the ordering module of their hospital electronic medical record (EMR) system.
The Jewish General Hospital (JGH) in Montreal has also implemented MedCurrent iReferr CDS. Dr. Huy Le, the chief of Radiology at the JGH says his institution is at Canada’s forefront of implementing CDS because of its history of integrating technology. “Dr. Lawrence Rosenberg, the CEO of our institution, had a vision for adopting digital health many years ago, which included pertinent applications in medical imaging.”
Dr. Le says this approach led JGH to successfully create an electronic Order Entry System (OES) earlier this year, now in production and testing phases with clinicians. The interfacing of CDS with the OES was done in parallel with testing and is currently functional.
Meanwhile, Alberta Health Services has integrated a CDS system, called CareSelect, which is primarily focused on CT and MRI. CareSelect is integrated with their Epic EMR, AHS’s electronic health record system and it is about two thirds of the way through provincial implementation. CareSelect relies on referral guidelines from the American College of Radiology (ACRselect) to categorize referrals as low, medium, or high value.
Dr. Bill Anderson, former Provincial medical director, AHS, says the current status of the CDS implementation is a data gathering mode; he believes this technology can be used for targeted quality improvement work. He further states that “in the future this system can incorporate active alert messages to referring physicians, which will help to guide referrals to medical imaging for patients.”
In Canada we need to look to these examples and build on the successes,
identifying best practices for the development of CDS referral system for radiology. This is not limited to medical imaging. Once developed, this system could act as a blueprint for other specialties in Canada.

“Imaging referral guidelines should be collaborative non-punitive tools, designed to improve quality, safety, and relevance. Our work in bringing a CDS solution online at North York General Hospital has demonstrated the need for Canadian-specific referral guidelines. Collaboration with all stakeholders, including patients and referring providers is needed to create comprehensive Canadian guidelines, designed to improve care for Canadian patients and families,” said Dr. Margau.
It is not only radiologists who agree with this approach. Dr. Paul Pageau, co-chair, CAR Imaging Referral Guidelines Working Group and director, Point-of-Care US, Department of Emergency Medicine, The Ottawa Hospital and assistant professor, University of Ottawa says that “we need
to work collaboratively with the broad spectrum of referring medical professions to make informed decisions regarding the selection of medical imaging tests and treatments. Having easily accessible Canadian guidelines will help us achieve this.”
The federal government has committed to investing $2 billion in new funding to address wait times for procedures
including diagnostic imaging. This will help to increase the number of CT and MRI scanners across the country. The national implementation of CDS would help ensure that these new resources are used as efficiently as possible.

There is an opportunity to improve overall effectiveness of referrals for medical imaging in Canada. By integrating CDS systems in all jurisdic-
tions, radiology departments could potentially reduce diagnostic imaging backlogs, streamline care for priority procedures, improve radiologist workload, and better measure and assess imaging requests across the country. The ultimate goal is improved patient care for Canadians and enhanced productivity for provincial healthcare systems. ■ H

The CAR Journal (CARJ) continues to be an important educational pillar of the radiology community in Canada and internationally. The Journal brings together the best work and scientific activities from radiologists who engage with the field’s most challenging topics and earlier this year, reached an all-time high Impact Factor of 4.186.
Dr. Mona El Khoury, from Montreal, is an Associate Editor with the CARJ and believes the role of the journal is to offer answers to the immense challenges of daily practice, while keeping radiologists updated with current scientific knowledge, even as it constantly changes. “Unlike many other scientific journals, the CARJ equally addresses many educational
issues, practical guidelines, and new innovations.”
“The CARJ owes its success to Canadian radiological community,” says Dr. Michael Patlas, Editor-in-Chief. “Many accomplished colleagues sent their incredible work to us and over 100 CAR members volunteered their time to review CARJ submissions.”
Associate Editor Dr. Alison Harris, from Vancouver, views the journal as an important platform for highlighting Canada’s radiology research that is having an indelible impact on the profession. “The CARJ provides a unique opportunity to feature research generated in Canada and highlight Canadian specific guidelines that can influence clinical practice and patient care.”
The strength and uniqueness of the CARJ derive from its compre-
hensiveness, says Dr. El Khoury. “All radiologists can find what they are searching for in the CARJ issues, from those in academic practice to those in community practice and radiologists-in-training.”
respected by the CARJ, which are very dear to my heart.”
The quality of MR imaging is defined by the trade-off between scan time, resolution and image noise. Improving one of these pillars usually requires compromising on one of the others. Deep Resolve, a deep learning solution for image reconstruction, can eliminate this dilemma. It enables clinicians to choose a significantly faster scan time while reducing noise and keeping the same resolution or even increasing image quality. Deep Resolve does not merely improve the final diagnostic image but starts at an even earlier stage: It works with the scanner’s raw data to use AI algorithms to improve the image from the first steps of image reconstruction. Speeding up scan time is especially valuable for patients who feel uncomfortable in MRI scanners, which is often the case for children, for example. Deep Resolve has great potential to shorten scan times by hooking into the very first step of image creation with all the available raw data. The Deep Resolve algorithms can therefore speed up scan times for brain MRI by up to 70 percent while doubling the resolution. Adding Siemens Healthineers’ unique Simultaneous Multi-Slice (SMS) technology can accelerate scan time further, by up to 80 percent. Deep Resolve is not limited to a particular region of the body and thus can help in almost every diagnostic procedure using MRI.
Find out more and discuss your needs.
customeradvocate.ca@siemens-healthineers.com
“The CARJ continues improving on its strengths. It is the premier Radiology publication in Canada, showcasing and publishing editorials on pertinent topics, ground-breaking research, and timely review articles,” says Dr. Harris.
Dr. Daria Manos, Associate Editor in Halifax, echoes this statement from her colleague and credits the journal’s leadership. “It is a pleasure to witness the improved quality of submissions to the CARJ from Canada and around the globe,” she said. “Dr. Patlas has shepherded an impressive increase in Impact Factor and has ensured that the hard work of submitting authors is respected by a fast-tracked review process.”
For these Editorial Board members, being involved with the CARJ has been a professionally enriching experience throughout their careers. “I have appreciated every level of my involvement with the CARJ,” says Dr. El Khoury. “As a radiologist born and trained outside Canada, being invited first as a reviewer then as a member of the editorial board means a lot to me and reflects widely on the high values and principles of equity and diversity
“Reviewing for the CARJ isn’t just about giving back,” says Dr. Manos. “Being a reviewer keeps my knowledge fresh and improves my own research by giving me a different perspective into what makes research publishable.”
There is plenty of optimism about the trajectory of the journal. “The CARJ is reinforcing itself as an educational and informative tool,” Dr. El Khoury says. “The quality of articles and usefulness in daily practice make it a beneficial tool for radiologists-in-training as well as those who are already settled.”
Dr. Harris expects the CARJ to continue to grow and evolve alongside of medical imaging in Canada and beyond. “There is broad scope to highlight excellent research and promote clinical guidelines with an equitable, diverse and inclusive lens to accommodate the different practice settings throughout Canada and globally.”
“I would encourage all CAR members to be actively involved with the CARJ,” she continued. “There are many opportunities to participate either by submitting papers or reviewing articles, being a reviewer or by regularly following the excellent content either online or in the print version of the journal. Even if you are a new CAR member, the CARJ offers a way to engage with it and the radiology community.” ■ H
Mobilizing the power of networks with deep resolve
Deep Resolve is a deep learning image reconstruction technology that takes advantage of neural networks that accelerate MR scans, making them faster than ever before. Shorter scans boost workflow efficiency while improving the patient experience. Deep Resolve’s raw data-to-image reconstruction and very fast acquisition are game changers in MRI, helping generate actionable insights that can be diagnostically relevant.
• Deep Resolve is a raw data-to-image deep learning reconstruction technology that enables high SNR and radically accelerated image acquisition.


• Enabling all relevant contrasts in one go with multi-shot EPI and deep learning reconstruction for a total neuro exam in two minutes scan time.



Original: MAGNETOM Lumina, 3T
T2 TSE, PAT 1, TA 2:32 mins 28 slices, 0.4 × 0.4 × 2.5 mm³
Deep Resolve Boost¹ and Sharp: MAGNETOM Lumina, 3T T2 TSE, PAT 4, SMS2, TA 18 s 28 slices, 0.3 × 0.3 × 2.5 mm³

Rachel is a 29-year-old lawyer who is actively trying to conceive her first child. She is both excited and nervous and has begun asking her family and friends advice on planning for pregnancy. She is wondering whether she should wait to begin taking prenatal vitamins until she is pregnant, as she does not want to take supplements unnecessarily.
It is recommended that, if possible, women begin prenatal vitamin supplementation three months prior to conception. Most standard prenatal multivitamins contain folic acid, iron, and calcium. Talk to your doctor about your potential risks for fetal neural tube defects, to determine the correct dose of folic acid required. Every woman should be taking folic acid supplement prior to and during pregnancy.
Rachel has been taking Escitalopram for depression for the past five years. Her depression was well controlled, and she is now stable on her medication. She was told by a friend that since many medications are unsafe to the developing fetus, women should stop taking medications when they become pregnant. Rachel is extremely worried about this.
Not all medications are contraindicated in pregnancy and may be continued under safe and effective medication management. However, it is always important to talk to your
doctor and consider individual patient factors, determining the benefits (of taking, continuing, or starting medication(s)) versus the risks (of not treating or managing your medical condition(s) during pregnancy). Pregnancy consists of three trimesters, where different stages of fetal development are taking place. Some medications should be avoided during the first trimester (e.g., decongestants). Other medications increase the chance of birth defects and should be avoided in the second and third trimesters (e.g., ACE Inhibitors that are used to lower blood pressure). Finally, some medications are absolutely contraindicated (e.g., isotretinoin, an acne medication, should not be taken during pregnancy or by women who may become pregnant, as it will very likely cause birth defects). [Readers can learn more about medication use during pregnancy at MyHealth.Alberta.ca https://myhealth. alberta.ca/Health/Pages/conditions. aspx?hwid=uf9707]
In the case of Rachel, she is stable on an antidepressant prior to becoming pregnant. No concrete evidence has been found to support an increased baseline risk of congenital anomalies with most of the first-line antidepressants, including her medication, Escitalopram. If a patient is on a medication
at the time of pregnancy and the condition is under control, the recommendation is to continue treatment during and after pregnancy, to prevent relapse of the condition. One notable exception is Paroxetine, which may increase the risk of cardiac malformations in the first trimester. On the other hand, untreated depression can come with its own risks, such as early pregnancy loss, low birth weight, post-partum depression, and even suicidal ideation. The bottom line is that many psychiatric medications may be used safely during pregnancy, provided that the benefits outweigh the associated risks.

Rachel is now two-months pregnant and struggling with “morning sickness”. She is confused why her nausea occurs throughout the day, and not just in the morning. She would like to use medications to help her feel better. However, she heard from her sister that they aren’t very effective, and the morning sickness will usually pass after the first trimester, so it’s best to avoid additional medications.
The term “morning sickness” is misleading, as nausea and vomiting often occur at all times of the day. Severity normally peaks at 11-13 weeks of gestation, and while many women experience relief after the first trimester, some continue to experience it throughout the remainder of pregnancy. Although evidence surrounding anti-nausea medications is conflicting, they are a reasonable and safe options, usually taken 4-6 hours before symptoms onset. If non-pharmacological management is preferred, oral ginger
and acupressure options are also available. [Readers can learn more about nausea and vomiting of pregnancy at UpToDate.com https://www.uptodate.com/contents/nausea-and-vomiting-of-pregnancy-beyond-the-basics]
It is now seven months later, and Rachel has delivered a healthy baby. She has decided to exclusively breastfeed for the first six months. She believes that, similarly to pregnancy, medication use during breastfeeding should be avoided, since it can pass into breast milk and affect the baby.
Not all medications that are unsafe in pregnancy are also unsafe during breastfeeding. Conversely, there are some medications that are safe in pregnancy, but generally avoided in breastfeeding. It is important to talk to your doctor about the benefits versus risks of medication use during breastfeeding, considering whether significant amounts of the drug are found in breast milk, and how the medication may affect the infant. It is also necessary to consider the maternal risks of not treating or managing medical condition(s) during breastfeeding.
Below is a list of other resources pertaining to safe medication use in pregnancy and breastfeeding:
• MotherToBaby https://mothertobaby.org/
• Drugs and Lactation Database (LactMed®) https://www.ncbi.nlm.nih. gov/books/NBK501922/
• European Network of Teratology Information Services (ENTIS) https:// www.entis-org.eu/
• Teratogen Information System (TERIS) https://deohs.washington. edu/teris/ ■ H
EVERY WOMAN SHOULD BE TAKING FOLIC ACID SUPPLEMENT PRIOR TO AND DURING PREGNANCY.




 By Sara Allin
By Sara Allin

t is increasingly apparent to researchers and the public alike that Canada’s healthcare systems need urgent action to deal with some critical challenges. Even before the COVID-19 pandemic, the strains were already there. A growing and aging population with inadequate long-term and acute care across the continuum. The increasing burden of chronic illness and multi-morbidity. Inequitable access to high-quality care. A workforce struggling to meet the demand. Now, those strains have reached the breaking point, affecting all parts of our healthcare systems, including hospitals and the people who work in them.
While change is hard, it’s clear we can’t keep doing things the way we always have. Continuing to invest more in health but not changing the way we finance, govern and deliver healthcare won’t solve the problem. We can learn from the experiences of the pandemic to find new ways to create more sustainable and resilient healthcare systems.








On November 16, we released our report – Sustainability and Resilience in the Canadian Health System – as part of a new research initiative with the Partnership for Health System Sustainability and Resilience (PHSSR), a global collaboration between academic, non-governmental, life sciences, healthcare and business organizations. Using a framework developed by the London School of Economics, and with input from an expert panel of health system decision makers, leaders and researchers across Canada, the report identifies the strengths, weaknesses, opportunities and risks of Canada’s healthcare systems across seven key domains.









None of the findings will surprise anyone who works in Canada’s healthcare systems or who has had any in-



teraction with them. The report recognizes the huge sums of money that governments spend on healthcare every year and a Conference Board of Canada forecast that spending must continue to increase in real terms over the next decade to ensure our health systems are adequately funded. But strengthening Canada’s ailing healthcare systems needs more than just money. That’s why the report makes a series of focused recommendations for systemic changes that could be implemented rapidly if all healthcare partners work together and collaborate.



Several recommendations relate directly to hospitals, but there are also others, such as reforming primary and long-term care that, if implemented, would help ensure patients receive care in the most appropriate setting.
The report calls on governments to implement a Pan-Canadian Health Data Strategy that would support the effective creation, exchange and use of critical health data for the benefit of Canadians and the health systems they rely on. And it stresses the importance of adopting interoperable, integrated electronic patient records systems to support the shift from provider-centric to patient-centric data. A strengthened data infrastructure across Canada is critical to improving health system planning, including of the workforce, and in monitoring and improving performance.
A key issue for ensuring the longterm sustainability and resilience of Canada’s healthcare systems is how to support health workers and deal with shortages, burnout and other challenges. Recognizing the increased stresses caused by understaffing and the additional burdens created by COVID-19, the report recommends improving working environments and increasing access to mental health support services. It also calls for action to combat systemic dis-
crimination and racism in the health system, and to strengthen education pathways for health workers from Indigenous, racialized and low-income communities to address inequities in the system.

It notes that, despite calls from experts and health workers alike, there is no Canada-wide approach to longterm workforce planning. Instead, workforce data and planning remain at the provincial or territorial level and vary significantly among jurisdictions and health professions. The report calls for strengthened integrated health human resource planning and evaluation, with enhanced workforce data infrastructure across occupations, sectors and jurisdictions, which could be supported by a pan-Canadian agency or body.
The report also examines governance within the healthcare system, calling for increased transparency in decision making and public reporting of health system performance at both
the system level and the organization or practice level, including hospitals. Public reporting, enabled by high quality data across all parts of the system, may help inform and empower patients and communities. It can also strengthen the accountability of governments to the public for the how their tax dollars are spent, and the accountability of providers and organizations for the value they provide with those investments.
The report also looks at how to strengthen care in the community to keep people out of hospitals as much as possible, with a particular focus on
primary care and home care. The report calls for scaling up innovative strategies and inter-professional teambased models of primary care, prioritizing underserved communities and optimizing the available workforce. It recommends taking a life-course perspective to plan for and invest in high-quality long-term care across the continuum of services and supports, along with improving the working conditions, education standards and full-time employment opportunities, with benefits and adequate wages, for aged care workers including unregulated workers.
In all, the report makes 29 recommendations across seven domains for improving the sustainability and resilience of Canada’s healthcare systems. The hope with this project is that the practical and action-oriented recommendations will be seriously considered by governments and health sector stakeholders. Their implementation will require a concerted effort by all involved.
Our healthcare systems have failed to evolve to meet the needs of Canadian patients and the healthcare professionals who care for them.
We know we need to do things differently.
We know it won’t be easy.
We also know that, if we don’t make some changes, we will not be ready for the next crisis and will never build the sustainable and resilient healthcare systems Canadians need and expect.
To read the full Canadian report, please visit: https://www.phssr.org/ findings ■ H
A KEY ISSUE FOR ENSURING THE LONGTERM SUSTAINABILITY AND RESILIENCE OF CANADA’S HEALTHCARE SYSTEMS IS HOW TO SUPPORT HEALTH WORKERS AND DEAL WITH SHORTAGES, BURNOUT AND OTHER CHALLENGES.
As the COVID-19 pandemic settled in over the course of the first half of 2020, few authors enjoyed as much renewed interest as the Algerian-born French existentialist Albert Camus. His classic 1947 novel The Plague tells the story of a town beset and isolated by an outbreak of the bubonic plague. The plague drags on and health authorities struggle to contain it. The population experiences a breakdown of civic order, a crumbling trust in institutions and the gradual onset of general paranoia. Sound familiar?
Joel Bothello, associate professor of management at the John Molson School of Business, recently published a paper on the topic in The Academy of Management Review. In it he asserts that Camus’s fictional plague, along with the very real Black Death of the 14th century and the lethal waves that followed, can be better understood using event system theory (EST). This relatively new theory to management studies reframes societal disruptions from isolated events to being the result of slowly unfolding chains of connected events: what happened prior to the pandemic or Chernobyl or the 9/11 attack, and what came after?
The long lead-ups and aftermaths of a calamity can provide a deeper understanding than just the study of the disruption itself, argue the authors. “Rather than it being about one event, we should look at each of these disruptions as an accumulation of events leading toward transformation,” says Bothello, who co-wrote the article with Thomas Roulet from the University of Cambridge.
Joel Bothello: “Even though we are supposedly more sophisticated now, the patterns that we see of human behaviour are very similar.”
Bothello and Roulet studied four books about past plague outbreaks, two fiction – The Plague and Daniel
By Patrick Lejtenyi Patrick Lejtenyi is Advisor, Public Affairs at Concordia University
Defoe’s A Journal of the Plague Year –and two nonfiction – The Black Death and the Transformation of the West by David Herlihy and In the Wake of the Plague: The Black Death and the World It Made by Norman Cantor.
They found that the distance of centuries has not changed the fundamental nature of human responses to disruptions or the profound changes that follow them. In all four books they found evidence of societal stagnation, disorientation, polarization and repudiation.
Stagnation refers to a population not recognizing or understanding the events within a chain and so fail to engage with it appropriately. Once the disruption occurs, the population experiences disorientation and no one knows how long it will take for life to return to normal. Polarization occurs when attempts to assign responsibility are shifted onto a particular group, often resulting in scapegoating and xenophobia. And then comes the repudiation of an existing system of beliefs and erosion of confidence in authorities, be they religious, civic or
scientific. These in turn lead to macro-level changes to economic, political and cultural norms.
“Even though we are supposedly more sophisticated now, the patterns that we see of human behaviour are very similar,” Bothello notes.
“We chose these particular books because they look at the Black Death through different levels of analysis,” he explains. “The novels capture the subjective experiences that, even though they are fictional, draw upon real events and real people. The nonfiction books look at the larger societal effects as well as the individual experiences of the people living through them.”
There is much to be learned from the disasters of the past, says Bothello, Concordia University Research Chair in Resilience and Institutions, given the right framework.
“EST helps us reconceptualize disruption, because disruption has usually been treated as a one-time jolt,” he adds. “If we apply this new lens to it, we can look at how events happen at different levels, how they connect with one another and how they even intersect with different event chains. We can look at disruption from a holistic perspective to see how it leads to changes in organizations and societies.”
Read the cited paper: “An Event-System Perspective on Disruption: Theorizing the Pandemic and Other Discontinuities through Historical and Fictional Accounts of the Plague.” ■ H
Arecent study led by Drs. Tereza Martinu and Bryan Coburn at Toronto General Hospital Research Institute looked at how chronic acid reflux –known as gastroesophageal reflux disease – affects the communities of microbes found in the lung.
The composition of microbial communities in the lung after transplantation differs between people and can be associated with lung dysfunction and inflammation.
had varying densities but with species that often cause infectious disease. This third type was more likely to be associated with lung inflammation and dysfunction.
Individuals with chronic acid reflux were more likely to have the first type of profile.
“We found that patients with chronic reflux had increased bacterial density with more species that are commonly found in the mouth,” says Dr. Martinu, who is also a lung trans-
“We wondered whether chronic reflux changed the microbial community, or microbiota, in the lung after transplantation,” says Dr. Martinu.
To explore the effect of chronic reflux on lung health after transplantation, the research team compared samples of lung microbiota from individuals who received a lung transplant between 2010 and 2015. Of these individuals, 24 of them experienced chronic acid reflux in the first year after transplant and 51 did not.
Analyses of the data revealed that the density and diversity of the microbial community differed in those with chronic reflux, compared to those without reflux. However, those with the condition were not more likely to experience inflammation and dysfunction of the lung.
When the team considered all samples from the 75 individuals that participated in the study, they identified three different types of microbial community profiles: the first type had high bacterial density, with species that are commonly found in the mouth. The second type had low bacterial density. And the third type

plant physician at UHN’s Ajmera Transplant Centre and associate professor of Medicine at the University of Toronto (U of T). “Despite having higher levels of bacteria, these individuals did not experience more lung dysfunction than those without chronic reflux in general.”
“Chronic acid reflux is an important modulator of the microbial community in the lung after transplantation. Future studies of chronic reflux in the context of transplantation should include the microbial community profile as part of the assessment,” concludes Dr. Coburn, who is also an assistant professor of Laboratory Medicine & Pathobiology at the U of T.
Rapid tests for lung microbiota may be useful predictors of disease to help lung transplant recipients manage their health in the future.

This work was supported by the Canadian Institutes of Health Research, UHN’s Ajmera Transplant Centre, U.S. National Institutes of Health, Comprehensive Research Experience for Medical Students Program, Cystic Fibrosis Foundation and UHN Foundation. ■ H
Best
This is why Sani Marc offers its Sani Marc eAcademy®, an online training platform that provides a wide range of interactive courses, video demonstrations, protocols and more. This value-added service is offered exclusively to Sani Marc clients*.
*Certain conditions apply.
Learn more at: Sanimarc.com/eacademy
ANALYSES OF THE DATA REVEALED THAT THE DENSITY AND DIVERSITY OF THE MICROBIAL COMMUNITY DIFFERED IN THOSE WITH CHRONIC REFLUX, COMPARED TO THOSE WITHOUT REFLUX.
practices are just as important as having the best products.
Click to train and learn to protect
The Centre for Aging + Brain Health Innovation (CABHI) is seeking solutions on behalf of six Ontario-based healthcare organizations enrolled in the Discover and Adopt (D+A) program.
If you are an innovator with a solution that can address one or more of the organizations’ needs listed below, apply today.
A virtual platform that healthcare professionals can use to easily manage patients and to support appropriate medication use by older adults receiving virtual geriatric care.
Problem Statement: This Ontario-based healthcare organization is seeking a virtual platform for healthcare professionals to easily manage patients and perform medication optimization (i.e., increase adherence and
reduce errors) to improve the frequency and quality of care for at-risk older adults.
Desired Outcomes:
• Increase staff satisfaction by 10-15 per cent in delivering virtual care for this population.
• Expedite medication optimization (increase medication adherence and reduce errors) for patients while they are waiting to see a geriatrician.
• Increase patient satisfaction by 10-15 per cent in receiving geriatric services faster and in the convenience of their own home, reducing patient and caregiver burden for transportation.

An automated system that enables the monitoring and replenishment of medical supplies on nursing units.
Problem Statement: This Ontario-based healthcare organization is seeking a supply room replenishment
system that allows for real-time data on the medical supplies on the nursing units, that requires minimal intervention by clinical staff, and limits the movement and intervention of support staff responsible for this task.
Desired Outcomes:
• Increase productivity of nurses and supply management team.
• Reduce stock out events and time clinical staff spend on requesting supplies.
• Eliminate supply management hours spent in the replenishment process.
• Reduce inventory level and optimize mix of product on the nursing unit
A solution that increases the social participation and engagement of residents in senior care organizations.

Problem Statement: This Ontario-based healthcare organization is seeking a solution to improve the so-
cial experience of long-term care residents, with for declining cognitive abilities and/or differing communication abilities, through engagement and activation strategies that are tailored to their individual needs and interests.
Desired Outcomes:
• Increase social participation and engagement of residents by 20 per cent from baseline.
• Improve quality of life of residents (increase QoL survey score related to meaningful activities by 10 per cent).
• Improve family satisfaction with engagement of residents through proposed solution (more than 60 per cent of families agree that the solution is beneficial to their loved one; 10 per cent increase on QoL survey score related to meaningful activities).

Home care is about trust. It is feeling comfortable with a provider coming into the home of someone you care for and, possibly, Bayshore’s home care services are extensive, tasks or round-the-clock care, Bayshore’s caregivers can help your loved ones to live
Let’s talk. 1.877.289.3997

A remote care monitoring solution that improves safety and reduces adverse events for those living in the community with responsive behaviours.
Problem Statement: This Ontario-based healthcare organization is seeking a Remote Care Monitoring (RCM) solution that will support people living in the community with responsive behaviours to stay safe and reduce adverse events (e.g. wandering, missed medications, falls) leading to poorer health outcomes and higher care utilization.
Desired Outcomes:
• Reduce adverse events reported over time by 20 per cent (e.g. trends/trajectories of incidents of wandering, falls, and medication adherence).
• Increase ability of clients/family to manage chronic medical conditions.
• Increase ability of clients/family to access healthcare system.
• Increase number of referrals to RCM program.
• Decrease number of police interactions for wandering.
• Decrease number of 911 calls, unnecessary emergency room visits and hospitalizations related to adverse events.
• Enable clients to live in the community longer.
A solution that enhances risk assessment and monitoring of older patients so they can be safely discharged following an emergency department visit.
Problem Statement: This Ontario-based healthcare organization is seeking a solution to support older patients return to home safely following an emergency department visit, and in turn reducing unnecessary overnight admissions and return visits to the emergency department within 72 hours.
Desired Outcomes:
• Increase patient satisfaction with the availability, accessibility, and use of the solution during care discussions.
• Staff satisfaction as related to accessibility of the solution and integration into clinical workflow, including: (a) maintenance of the solution and (b) potential downtime.
• Reduce unnecessary overnight admission to the ward of older patients.
• Reduce the number of return visits by older patients to the emergency department within 72 hours.
• Reduce the average length of stay in the Emergency Department for older patients who can be discharged safely to the community.

A solution to reduce the workload related to meal service in the dining room in senior care organizations.
Problem Statement: This Ontario-based healthcare organization is seeking a solution to reduce the workload related to meal service in the dining room in senior care organizations.
Desired Outcomes:
• Reduce walking distance and/or steps taken by dietary team members by at least 60 per cent during a single meal.
• Reduce the amount of time dietary team members spend carrying trays of plates by at least 60 per cent.
• Reduce the amount of time required to serve a seating in the dining room.
• Reduce the amount of time required to clear the dining room per seating.
• Increase resident mealtime satisfaction in at least 80 per cent of residents.
• Increase team member mealtime satisfaction in at least 80 per cent of team members. ■ H
IF YOU ARE AN INOVATOR WITH A SOLUTION THAT CAN ADDRESS ONE OR MORE OF THE ORGANIZATIONS’ NEEDS LISTED HERE, PLEASE APPLY TODAY.
Canada needs trauma-informed aged care, training and strategies in long-term care homes across the country.
“Trauma” is a heavy word, but it’s the right word.
“Trauma” describes what has been happening in long-term care facilities across Canada during the pandemic, where the majority of COVID-19 deaths have occurred, and where highly restrictive visitor policies and short staffing have meant extreme isolation and deprivation for the residents who live there.
But there are often two layers of trauma in long-term care.
Overlooked in these discussions is how the pandemic can also trigger symptoms of post-traumatic stress disorder (PTSD) in seniors who have experienced psychological trauma earlier in their lives. Earlier trauma could have resulted from any number of events that caused deep psychological harm, such as a car accident, physical or sexual abuse or fleeing an armed conflict, for example.

In our recently published analysis and review, we highlight how PTSD in long-term care residents is significantly more common than previously understood, how the pandemic has exacerbated PTSD in some residents, and recommend ways that nursing homes can manage the effects of trauma.
While not everyone who has experienced trauma will develop PTSD, those who do are likely to see symptoms re-emerge as they age, develop dementia or are admitted to a long-term care home, which can also be a traumatic event in itself. For vulnerable seniors living in care, the spread of a deadly virus can also trigger intense PTSD symptoms including intrusive thoughts, nightmares and feelings of panic.
Well over two thirds of seniors living in long-term care have some form of dementia. PTSD symptoms can oc-

cur when practices or environmental sights and sounds in the home inadvertently trigger an individual. When this occurs on top of dementia, it may cause extreme behaviors.
What’s more, symptoms associated with PTSD are similar to behaviours exhibited by those living with dementia such as anger, aggression or agitation. Since long-term care homes do not routinely screen for a history of psychological trauma on admission, staff may have a difficult time identifying which behaviours stem from PTSD and which stem from dementia.
All of this points to an urgent need for more person-centered care and well-trained staff who are equipped to meet the needs of residents.
Through trauma-informed practices, ensuring the quality of life of residents becomes an achievable goal
and individuals living with PTSD will receive the care they need.
With the proper resources and training, nursing homes can be transformed into places worth living.
So, what does trauma informed care look like?
It means creating a safe environment with adequate staffing, training the workforce, screening residents for trauma upon admission and taking a personal history to be used as the basis for future care. It means management consults residents, their loved ones, and staff in all aspects of care planning as well as providing staff with access to specialized services like mental health teams.
It means incorporating strategies to support residents that focus on bodily senses to address symptoms and behaviours associated with PTSD. This
includes the use of weighted blankets, music, breathing exercises or animal-assisted therapy to increase sleep quality, improve mental health and decrease pain and agitation.
A trauma informed approach also means centering staff well-being.
When visitation from caregivers and companions became severely restricted, staff who already did not have time to provide residents with adequate care saw their workload increase. Additionally, staff dealt with the moral injury of watching residents suffer and die alone.
Burnout levels amongst staff are nearing catastrophic levels and supporting staff with trauma means introducing cognitively based processes that regulate attention and set intention or somatic-based processes such as modified yoga therapies and stress reduction strategies.
While policy makers develop important industry wide standards and practices, we need to work locally towards fully integrating trauma-informed methods into long-term care homes across the country.
COVID-19 is a psychological wrecking ball and only trauma-informed practices and policies can build a sturdier system able to withstand the next pandemic or catastrophic event. This requires a commitment from those managing long-term care homes to work towards ensuring a trauma informed approach in their facilities.
Staff must be equipped with the basic knowledge of the effects of trauma and receive training on how to integrate this knowledge into their daily care routines. Additionally, supporting residents as well as staff means providing them with access to educators, nurse practitioners and those who have specialized knowledge of mental health.
Vulnerable seniors in LTC have suffered enough. It’s time for policymakers, funders and long-term care home managers to prioritize trauma-informed aged care. ■ H
Keep residents connected to the people and things they love the most. With Managed Wi-Fi, TELUS Business makes it easy to connect residents to their own personal area network. Our property-wide Wi-Fi is secure and reliable, our technology is easy to learn and use, and we offer bilingual 24/7 technical support for residents and employees.

In June 2022, the Ottawa Paramedic Service and Hôpital Montfort launched a pilot program that integrates Primary Care Paramedics into the Montfort Emergency De-
partment. The program aims to reduce paramedic offload delays, increase the availability of paramedic resources in the community, and improve patient flow within the hospital. “The challenges we face in healthcare are requiring us to rethink the way we do things and to challenge the status quo”, ex-
plains Martine Potvin, Vice-President, Patient Experience, Clinical Programs and Chief Nursing Executive at Hôpital Montfort.
The program includes four Primary Care Paramedics working 12-hour shifts in Montfort’s Emergency Department, providing 12-hour coverage,
seven days a week. When an ambulance arrives, the patient’s care can be transferred from the transporting paramedic crew to the paramedic working in the Emergency Department. This allows the paramedic crew to return to the community so they can be available for the next call.
As the Eastern York Region North Durham (EYRND) Ontario Health Team (OHT) wraps up its second year since the Ministry of Health officially announced its establishment, collectively, it has been able to provide the community, Markham, Stouffville, Uxbridge and beyond, with an integrated system of care.
“Over the past two years, the pandemic has challenged us in ways we never imagined,” says Dr. Cristina Popa, Co-Chair, Core Leadership Council, EYRND OHT. “However, we continued delivering on our strategic priorities and bridging recovery through innovation to enhance the experience of individuals, caregivers, primary care providers, worked to improve population health, health equity and implemented integrated care delivery models.”
The EYRND OHT is a partnership of a number of health and non-health partner organizations that share a rich history of collaboration and an exciting vision for the future of health care in our communities. The EYRND OHT includes:
• 360 Kids
• Addiction Services Central Ontario
• Canadian Mental Health Association York and South Simcoe
• Care First
• CHATS Community & Home Assistance to Seniors
• East Markham Family Health Organization
• Entité 4
• Health for All
• Krasman centre
• Markham Family Health Organization
• New Unionville Home Society
• SE Health
• SRT MedStaff
• York Region
• York Support Services Network
• Oak Valley Health
“This past year through community partnerships, and a perseverance to improve the lives of people and families in our communities, we rose to the challenge and are forging the road ahead,” says Dr. Popa. The following are a few of the many EYRND OHT current initiatives that are paving the way:
In partnership with 12 community organizations, EYRND OHT supported the largest mass vaccination centre in York Region the COVID-19 Community Vaccination Centre at the Cornell Community Centre. In over 56 weeks, over 270,000 shots were given with an average of 600 shots per day, up to a max of 2,752 per day including the pop-up vaccination clinics.
Volunteers, staff, community partners and health care providers in the community came together quickly. The centre was paired with outreach efforts to ensure vulnerable residents in congregate settings (long-term care, retirement homes, and group homes) were supported and protected. Popup swabbing clinics and vaccination clinics were set up in high-priority communities to improve access and increase uptake. A key element that set the vaccination centre apart was that
it was one of the few centres in the GTA that provided additional monitoring in the Emergency Department for people with special needs such as severe allergies.
The COVID-19 Assessment Centre, supported by the EYRND OHT, has also helped the health care system over the last two years successfully in many regards, and as the pandemic is changing so are the COVID-19 related services. In partnership with Oak Valley Health, the COVID-19, Cold, and Flu Care Clinic (CCFCC) opened to address underserved and hard-toreach populations, find solutions for high volumes of patients without a primary care provider, provide access to primary care assessments, and divert Emergency Department visits.
Connecting primary care providers to hospital-based resources and specialty services (e.g., General Internal Medicine, mental health, diagnostic imaging, wound care, Medical Day Unit, etc.) through a nurse navigator based at Oak Valley Health, SCOPE aims to improve value and efficiency through reducing visits to the Emergency Department. In partnership with Oak Valley Health and Women’s College, the goal is to improve patient’s access to care, reduce admissions for investigation, improved primary care provider and patient experience, time and human resource efficiencies and effort, and improve service wait times. Since launching in April 2022, SCOPE has on-boarded 100 physicians
and the number is growing. Additionally, primary care providers’ access to SCOPE increased by 66 per cent in the sixth month of operation. This means equitable and timelier access to specialty care while primary care providers remain in control of patient care.
Streamlined Access is York Region and South Simcoe’s advanced, localized solution to coordinated access to Mental Health and Addiction services. Streamlined Access provides access and navigation to 26 individualized community-based programs which can be categorized into three “baskets of services”: Mental Health Case Management, Mental Health Supportive Housing and Assertive Community Treatment Teams.
The goals of this initiative includes improved provider experience by reducing the burden on primary care providers (PCP) through establishing a single, integrated and coordinated point of access for community-based mental health and addictions referrals; improved patient experience by providing advocacy and follow up on behalf of patients and family caregivers during the referral process.
Together, the EYRND OHT is working to redesign care for residents of its communities in Markham, Stouffville, Thornhill, and Uxbridge as well as for clients and families who use services in the communities but live elsewhere. For more information about the EYRND OHT, visit our website EYRND.ca ■ H
While working in Montfort’s Emergency Department, each paramedic can monitor and care for up to four patients at once. The paramedics work within their professional scope of practice under the medical direction of an Emergency Department physician. The Emergency Department physician provides the paramedics with the authority to perform various medical procedures and diagnostic tests. This promotes improved patient offload, continuity of care, and patient flow within the hospital. Montfort is the first hospital in our city to implement this integrated approach.
Daily, Montfort is seeing a reduction in paramedic offload delay in the Emergency Department. For example, over the course of one day in September, one paramedic eliminated over 30 hours of offload delay by caring for seven patients during their shift.
Montfort covers the staffing costs of the Primary Care Paramedics working there. The program was initially piloted for a three-month period and owing to its success has been extended until September 30, 2023.

“The integration of paramedics into our emergency team is one example of how we are rethinking the way we work”, adds Ms. Potvin. “It is also a reflection of the resilience of our staff, who are dedicated to providing an exceptional experience, with you, for you.”

The partnership between the Ottawa Paramedic Service and Hôpital Montfort demonstrates the innovation
and leadership of both organizations in responding to community needs, requests for service and an ever-changing healthcare landscape.
“This program is just one of the impressive efforts by the Ottawa Paramedic Service to continuously improve its services to our growing city”, said Jim Watson, speaking at one of his last event as Mayor of the City of Ottawa. “My thanks to Montfort for its
leadership in this important initiative.”
“On behalf of the Ottawa Paramedic Service, I am proud to partner with the Montfort on this exciting initiative and remain committed to working with local hospitals to identify additional strategies for reducing offload delay and increasing our ability to respond to the needs of Ottawa’s communities”, added Pierre Poirier, Chief of the Ottawa Paramedic Service. ■ H

